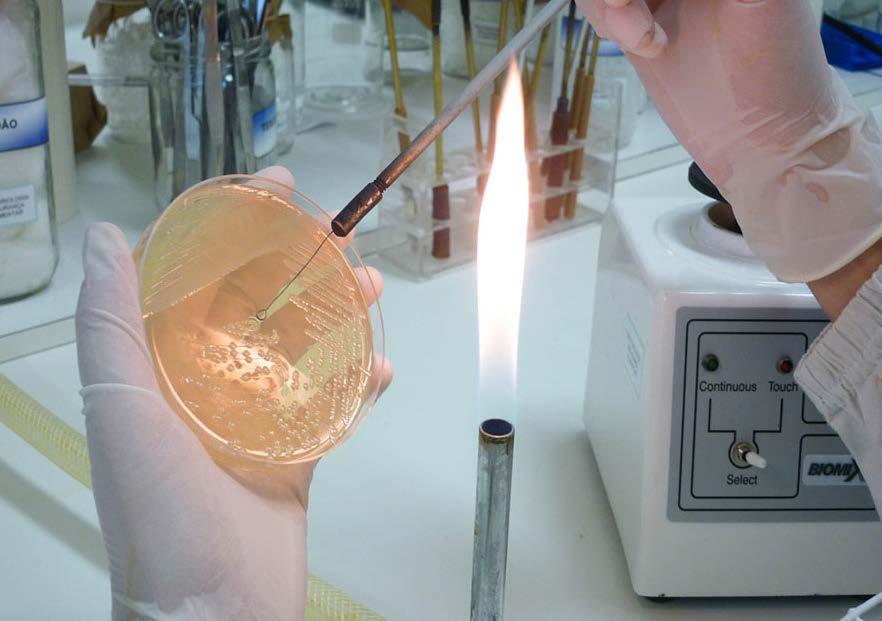

D. João Carlos Seneme completou uma década como bispo da Diocese de Toledo, concentrando seu ministério na atenção pastoral a esta parcela do Povo de Deus no Oeste do Paraná. São dez anos de atuação discreta, com olhares fixos e atitudes pautadas no Evangelho que conduzem os fiéis na fraternidade e em gestos de amor ao próximo. É assim que D. João exerce seu ministério: com confiança e esperança no Senhor.
Neste período, foram construídos três Planos Diocesanos da Ação Evangelizadora, que acompanharam as diretrizes da Igreja no Brasil, com atividades, projetos e iniciativas próprias. Soma-se a todo esse serviço de seu ministério episcopal a continuidade da nova metodologia da Iniciação à Vida Cristã e os esforços na questão vocacional, bem como a criação de novas pastorais – serviços da Igreja –para o atendimento das necessidades dos fiéis e da população crescente. Tanto que em 2015 foi criada a Paróquia Santa Rita de Cássia e agora está em preparação a criação da Paróquia Nossa Senhora Aparecida, ambas em Toledo. Na assistência social, mais recentemente, foi inaugurada a Casa de Maria, na cidade de Marechal Cândido Rondon, que presta atendimento diário, em contraturno escolar, a 90 crianças e adolescentes.
D. João tem hoje 37 anos de sacerdócio e completará em dezembro o


D.


16º aniversário de episcopado. Logo nos primeiros meses de governo na Diocese de Toledo, por ocasião deste tempo tão belo para os católicos que celebram Nossa Senhora Aparecida, o bispo diocesano escreveu a este povo: “A Igreja nos ensina que o discurso sobre Maria vai além do simples afeto, pois ele passa por Jesus Cristo, Ele é o ponto de referência: a mensagem de Maria exige de nós uma fé autêntica e amadurecida em Jesus Cristo. Somente Cristo revela o mistério de Deus: Ele é a imagem autêntica do Deus invisível. Só assim podemos entender o mistério que envolve Nossa Senhora que diz: ‘Eu aceito participar deste projeto de salvação. Faça-se em mim segundo a tua vontade’. Cristo será sempre Deus e Maria sempre criatura. Maria nos conduz a Cristo e Cristo nos conduz a Deus”. Esta reflexão de D. João convida os diocesanos ao testemunho da confiança em Deus na superação de seus desafios, sendo sabedores que a Mãe Aparecida os acompanha nesta jornada.
A experiência que cada um vivenciará com as festividades da Padroeira do Brasil e de, ao menos, cinco paróquias pertencentes à Diocese de Toledo – entre tantas capelas – ficará registrada no coração de cada devoto, faça ele uma procissão longa ou apenas levante o terço para rezar invocando a Virgem de Aparecida.
Boa Leitura!
década de pastoreio na Diocese de Toledo
Diocese de Toledo Promove o 1º Mutirão de Comunicação”

Jovens da Diocese de Toledo celebram os 50 anos da Pastoral da Juventude

Sicoob fica entre as 10 principais instituições financeiras no ranking Valor 1000



Tratamento da AME tem mais efeito

João CarlosSeneme:
uma

Iniciamos o mês de outubro, dedicado às missões. Somos convidados a rezar pela realização da primeira etapa universal do Sínodo sobre a Sinodalidade – “Por uma Igreja Sinodal: comunhão, participação e missão” que será realizado em Roma. Já passamos pela etapa diocesana, depois houve uma etapa continental e agora acontecerá a primeira etapa universal. A Igreja sinodal, chamada a ser a Igreja do terceiro milênio, tem seu fundamento no caminho do Reino de Deus. O caminho sinodal implica conhecer, amar e seguir Cristo, fazendo o bem aos outros. Os conceitos de Igreja em saída e Igreja sinodal estão intrinsecamente ligados. Colocar-se em atitude de escuta foi o pedido mais enfático do Papa Francisco ao convocar o Sínodo.
A identidade da Igreja está em sua missionariedade: “Ide pelo mundo e fazei discípulos entre todos os povos da terra. Eu estarei convosco sempre, até o fim do mundo” (Mt 28,19-20). Precisamos constantemente percorrer um caminho de animação missionária e sensibilização das nossas comunidades para participarem e assumirem a missão universal da Igreja.
Para o Dia Mundial das Missões deste ano, o Papa Francisco escolheu um tema que se inspira na história dos discípulos de Emaús, no Evangelho de Lucas (24,13-35): “Corações ardentes, pés a caminho”. Através da experiência destes dois discípulos que, no encontro com Cristo res -
suscitado, se transformam em missionários ativos, o Papa Francisco recorda, antes de tudo, o valor da Palavra de Deus para a vida dos batizados: O conhecimento da Escritura é importante para vida do cristão, e ainda mais para o anúncio de Cristo e do seu Evangelho. Jesus é de fato a Palavra viva, a única que pode fazer arder, iluminar e transformar o coração”. Em uma segunda passagem da sua mensagem, o Papa sublinha a importância da Eucaristia: Devemos lembrar que uma simples partilha do pão material com os famintos em nome de Cristo já é um ato missionário cristão. Mais ainda, a fração do Pão Eucarístico, que é o próprio Cristo, é a ação missionária por excelência, porque a Eucaristia é fonte e ápice da vida e da missão da Igreja. Por fim, o Papa nos recorda a importância de manter viva a missão através do empenho de cada um e da oração pelas vocações missionárias: A imagem dos “pés a caminho” nos recorda mais uma vez a validade perene da missio ad gentes , a missão dada à Igreja pelo Senhor ressuscitado de evangelizar todas as pessoas e todos os povos até o fim do mundo.

O mês missionário tem o seu ápice na celebração do Dia Mundial de Orações pelas Missões que acontecerá no penúltimo domingo do mês, 22 de outubro. Neste dia todas as comunidades se unem espiritualmente a todos os missionários envidados ao mundo para anunciar o Evangelho e, através de uma oferta em favor das Pontifícias Obras Missionárias, todas as pessoas reunidas ao redor da mesa eucarística podem contribuir com os missionários e com as comunidades carentes espalhadas ao redor do mundo.
“Ide! Da Igreja local aos confins do mundo” é o tema da Campanha Missionária de 2023, cuja inspiração bíblica, baseada no texto dos discípulos de Emaús, é “Corações ardentes, pés a caminho” (cf. Lc 24,13-35). A Campanha Missionária deste ano, põe em evidência que cada Igreja local tem o dever de evangelizar toda pessoa e todos os povos até os confins da terra. Destaca-se que este entusiasmo missionário nasce da experiência do amor de Cristo que cativa e impulsiona todos os cristãos.
D. João Carlos Seneme, CSS Bispo da Diocese de Toledo





Um bispo da Igreja Católica Apostólica Romana é um pai que tem sobre seus ombros a responsabilidade de guiar em Cristo os passos da parcela do povo de Deus que lhe é confiado. É uma missão bastante exigente que se expressa em compromissos e desafios, mas também em superações e alegrias alcançadas pela graça do Senhor. Por sinal, graças que têm recaído sobre D. João Carlos Seneme em seus dez anos


“Para nós bispos o que traz mais felicidade é o trabalho vocacional e a ordenação de padres. São elementos que nos marcam. Afinal, temos que pensar na manutenção da evangelização e para isso precisamos de gente”.
como bispo da Diocese de Toledo, completados em 2023. Por hora, é o terceiro mais longevo pastoreio nos 64 anos da Diocese, depois de D. Armando Círio (18 anos) e D. Lúcio Ignácio Baumgaertner (13 anos). Nesse período, é visível que
se realiza a colheita de bons frutos nos campos pastoral e administrativo, bem como continuam sendo cultivados os campos da evangelização.


D. João tem um jeito discreto de governar, pelo qual transmite serenidade e tranquilidade naquilo que no modelo empresarial se chama de gestão. Moderado, segue o caminho da reflexão antes de tomar as decisões a fim de que estas expressem a colegialidade e sejam seguras aos fiéis. Passou por grandes desafios nesta década, como a pandemia de covid-19, a perda de alguns membros do clero e tensão política, mas são maiores os avanços alcançados na organização pastoral diocesana, na ampliação do atendimento assistencial a crianças e ado lescentes, nos fortes investimentos na questão vocacional e, mais recentemente, com a campanha “Domingo, Dia do Senhor”, na tomada de consciência das próprias pessoas sobre a fé que professam.
O paulista, que aos 19 anos ingressou no Seminário da Congregação dos Sagrados Estigmas de Nosso Senhor Jesus Cristo (Estigmatinos), em Campinas, já viveu em São Paulo, Minas Gerais e Roma, além de duas passagens por Curitiba, sendo elas já como sacerdote formador e posteriormente como bispo auxiliar da Arquidiocese. Até que em junho de 2013 foi nomeado bispo diocesano de Toledo, tendo tomado posse em 8 de agosto daquele mesmo ano.
Desde a sua posse até os dias atuais,
D. João salienta que os fatos mais marcantes no período são as vocações, ordenações e crismas. Aliás, segundo levantamento da Chancelaria da Cúria Diocesana, até agora o bispo fez 570 celebrações eucarísticas com o Sacramento da Crisma para 22.898 crismandos. Impressionado, ele avalia com alegria por notar essa busca dos jovens pelo Sacramento. “O fato de receber o Sacramento da Crisma é a continuidade da vida cristã. Para mim é impressionante ver esse número tão significativo”, comenta.


Já as ordenações sacerdotais são as responsáveis pela maior felicidade do bispo. Até agora, foram oito realizadas de padres diocesanos no período, portanto para novos membros do clero de Toledo, e outras três ordenações para congregações da Sociedade Apostolado Católico, Ordem dos Agostinianos Descalços e Frades Menores Missionários.
OLHAR DE FUTURO
Governar uma diocese é também estar atento à expansão populacional das 19 cidades que formam a Diocese de Toledo. Afinal, são pessoas que certamente precisam de assistência religiosa, inclusive de acesso aos Sacramentos. D. João e o clero observam com muita atenção os números que o Instituto Brasileiro de Geografia e Estatística (IBGE) revelou no Censo Demográfico 2022: um crescimento populacional na região diocesana de 17%. Dos maiores núcleos populacionais, destacam-se no crescimento do número de habitantes no período 2010-2022: Toledo (+26,11%), Marechal Cândido Rondon (+19,26%), Palotina (+22,06%) e Assis Chateaubriand (+11,45%). Reflexões e análises não deixam de lado cidades com menor população e que apresentam carências em outros segmentos, inclusive no campo social.
Em Toledo, em vista dessa expansão demográfica, houve a necessidade de criação da Paróquia Santa Rita de Cássia, do Jardim América (2015), e da Quase-Paróquia Nossa Senhora Aparecida, do Jardim Pancera (2022). Outras atenções se voltam ainda para Jardim Coopagro, Biopark e demais regiões. Assis Chateaubriand também pleiteia a sua terceira Paróquia. Mas o ponto que esbarra para
que uma paróquia seja criada é ter padre disponível para atendê-la. É aqui que entra o ponto-chave da cultura vocacional que visa oferecer a chance para que o jovem possa pensar sobre o assunto de ser padre, conforme salienta o bispo diocesano.
Por sinal, essa temática vocacional segue na entrevista que D. João Carlos Seneme concede nesta edição da Revista Cristo Rei. Ele aborda ainda outros assuntos de relevância nestes dez anos de governo na Diocese de Toledo pautados pelo seu lema episcopal “O amor de Cristo nos impele”, inspirado pela 2ª Carta de Paulo aos Coríntios, pelo qual o Apóstolo menciona a experiência do amor de Cristo que deve impulsionar a vida dos fiéis numa atitude de seguimento na dedicação aos irmãos e irmãs.
Convidado para falar sobre estes dez anos de episcopado na Diocese de Toledo, D. João Carlos Seneme chegou até a Cúria numa tarde ensolarada e escolheu o estúdio da Voz da Diocese para conceder a entrevista. O estúdio é o mesmo que serviu para produção do programa que fez história nos mais de 24 anos em que esteve no ar nas emissoras de rádio e apenas foi readequado para o novo formato voltado à distribuição pelas redes sociais. Uma adaptação que D. João abraçou com toda a equipe para avançar no meio digital. Nesse espaço escolhido como ambiente da entrevista, destacou aspectos
cruciais para a caminhada evangelizadora na região. Há muito o que fazer, pois a sociedade é dinâmica, está em constante movimento e carece de referenciais para a convivência comunitária e prática de fé. É o que D. João tem percebido nas visitas constantes que faz às comunidades, por ocasião das crismas e celebrações dos padroeiros, onde dialoga com os fiéis. Também visitas pastorais formaram a agenda do bispo diocesano neste período, e uma Visita Ad Limina ao Papa Francisco onde apresentou farta documentação sobre a caminhada pastoral nesta região diocesana.
Revista Cristo Rei – D. João, já se passaram dez anos na Diocese de Toledo. É o terceiro governo mais longevo de um bispo. O que isso representa?
D. João – Para mim é também uma surpresa esse período longo. Mas ele é marcado por muitas coisas boas pela evangelização. Quando penso que já se passaram dez anos, parece que foi tão rápido. Está sendo uma experiência boa nesse sentido de poder estar aqui todo esse tempo e de ver uma linha de evangelização acontecendo que possa nos ajudar a fazer mais pelos fiéis. Em dezembro completo 16 anos como bispo, tendo cinco anos e meio exercido o ministério em Curitiba, como bispo auxiliar.
RCR – Em Curitiba como bispo auxiliar, e aqui como bispo titular. Isso causou algum impacto na sua vida?
D. João – O trabalho do bispo é cuidar da Diocese, seja no campo pastoral e no administrativo. Em Curitiba, sempre estive junto com o arcebispo, até porque éramos da mesma congregação. Já aqui em Toledo, como bispo titular, tem esse dado forte de que agora é minha responsabilidade. Esse fato foi marcante.

“A Casa de Maria é uma mostra de que a Igreja e sociedade devem trabalhar conjuntamente em prol de crianças e adolescentes. Em Marechal Cândido Rondon, demos um grande passo na caminhada de motivação e parceria entre Igreja e sociedade que reconhecem um projeto já testado e aprovado há 30 anos em Toledo”.

Houve sim essa diferença, mas não tive dificuldades porque fui muito bem acolhido. Além disso, a Diocese de Toledo sempre foi muito bem organizada pastoral e administrativamente. Assim fui acompanhando essa caminhada já realizada, pois não precisava iniciar do zero. Era simplesmente dar continuidade naquilo de bom já feito anteriormente.
RCR – O que lhe trouxe mais felicidade nesses dez anos?
D. João – Para nós bispos o que traz mais felicidade é o trabalho vocacional e a ordenação de padres. São elementos que nos marcam. Afinal, temos que pensar na manutenção da evangelização e para isso
precisamos de gente. Foram oito ordenações e com isso percebi que é aquilo que mais dá felicidade, assim como a união do clero. Claro que onde tem gente, podem ocorrer desencontros, mas no conjunto os padres são bem envolvidos seja na pastoral, na partilha, nos encontros, o que não é tão presente em cidades grandes. Aqui nós temos essa experiência de família.
RCR – Vamos falar da questão vocacional. Como era antigamente e como está?
D. João – Fui formador na minha congregação por mais de 15 anos. Era um período bem característico, sem internet e uma série de coisas que hoje para a formação é muito desafiador. Outro elemento é a questão do número de candidatos, até porque as famílias são menores, e parece que esse tipo de trabalho não atrai muito os jovens porque é um serviço constante e para toda a vida. De nossa parte, temos que lidar com a formação considerando esses sinais que o mundo de hoje apresenta e se tornou mais difícil.
RCR – Qual a sua leitura acerca desta realidade vocacional?
D. João – Havia um quadro em que a fa-
mília, o jovem e a comunidade buscavam essa proximidade. Naquela época, o estudo atraía muito. Hoje, o estudo oferecido para padre, como Filosofia e Teologia, parece não chamar tanto a atenção. Vejo que a pessoa que quer ser padre é aquele em que tem algo a mais dentro do coração e que vai fazendo esse discernimento. Se antes muitos entravam para ver o que era essa vocação, hoje os recursos que eles têm à mão não acentuam ou não privilegiam a vida de um padre porque a sociedade valoriza mais o trabalho pelo que se ganha financeiramente.
RCR – Diante deste cenário, o que a Diocese tem feito?
D. João – Conversando com outros bispos, percebo que temos um caminho diferenciado em prol da cultura vocacional. Falo do trabalho com as crianças e adolescentes, envolvidos como coroinhas e acólitos. Isso desperta um pouco esse interesse de conhecer melhor a vida sacerdotal. Esse caminho considero importante, além da aproximação com as famílias. Aqui na Diocese ainda temos uma estrutura favorável de família. Os nossos seminaristas vêm de famílias constituídas com pai e mãe. Em outros lugares isso não é tão forte, o que exige mais trabalho na formação. Pela Diocese ainda temos comunidades mais tradicionais que mostram claramente a família envolvida na Igreja e assim o rapaz que desperta essa vocação começa a entender melhor. Então, precisamos continuar nesse investimento para despertar vocações. É muito bom contar com padres que se interessam na formação permanente e fazem com que esse trabalho junto aos seminários, que são o coração da Diocese, esteja ali bem organizado. Já para as congregações femininas, muito deste trabalho vocacional é divulgado aqui mesmo pela Revista Cristo Rei, como forma de contribuir na visibilidade daquilo que elas vêm realizando, incentivando as vocações religiosas femininas por sua presença na vida comunitária.
RCR – Falamos de alegria vocacional, encontros formativos e ordenações como momentos felizes do bispo. Porém, impactante também foram as perdas sentidas no clero?
D. João – É muito mais impactante porque foram perdas de padres com tradição na Diocese, como de Pe. Raulino Cavaglieri, Pe. Hugo Rhoden – que foi nosso ecônomo por muitos anos. Foram cinco mortes nesse período, das quais três em apenas um ano. É o que mais machuca, sem dúvida, porque vemos uma vida vo-
cacional presbiteral interrompida.
RCR – O que mais lhe desafia no momento?
D. João – Estamos num contexto de muito planejamento. Falamos da questão vocacional que está diretamente ligada ao atendimento aos fiéis. Não temos padres em número suficiente para atender comunidades grandes. E o desafio é tentar administrar tudo isso. Soma-se o atendimento às pessoas nas suas necessidades e o crescimento populacional. Percebo que esse é um desafio: tentar fazer com que haja um trabalho de evangelização mais intenso.
RCR – O que dizer sobre a participação dos leigos nesse tempo de dez anos? Afinal, temos um quadro de Ministros Auxiliares e Catequistas, entre tantos líderes de pastorais e movimentos, que contribuem na evangelização.
D. João – A Diocese de Toledo conta com pessoas muito generosas em participar, que têm vontade e são convictas de que fazem isso pelo Batismo. Contudo, percebemos que não há muita renovação. Temos muitas lideranças, mas pessoal que se repete muito nos encargos. Claro que isso acontece no Brasil inteiro e está envolvida na questão da juventude participar mais dos serviços na Igreja. A grande dificuldade é despertar nos jovens e nos casais mais jovens esse amor pela Igreja e de dedicar um pouco de seu tempo para as coisas da Igreja.

RCR – Diante do desafio da renovação, nota-se que os fiéis ingressam em ações voluntárias similares que as pastorais e movimentos realizam. Por exemplo, Auxílio Fraterno: a Diocese tem espaço para voluntários atuarem, mas parte dos fiéis faz o mesmo serviço em outras entidades. Como D. João vê isso?
D. João – É um pouco o retrato do que mudou. Antes, era somente a Igreja que tinha esse papel de mobilização dentro da sociedade. Mesmo assim percebo que é positivo no sentido de que há sensibilidade das pessoas em fazer o bem, que é justamente o espírito cristão. Pessoas individualmente e coletivamente se mobilizam. Hoje a Igreja atende os pobres e evangeliza. Isso mostra que nossa Diocese e cidade cresceram muito no despertar do desejo de ajudar as pessoas. É uma atitude cristã movida por Deus. As pessoas às vezes podem até não fazer essas atitudes conscientemente por causa de Deus, mas pelo irmão e irmã. Contudo, ali está o cerne de Deus que despertou nessa
pessoa o olhar para não observar somente a si mesmo, mas para fora, para o outro.
RCR – Quais seriam as outras atenções do bispo diocesano?
D. João – A Iniciação à Vida Cristã é uma delas. Antigamente, dizia-se que a vida cristã era passada pelo seio da mãe quando amamentava a criança. Hoje a Igreja faz esse movimento pela ação evangelizadora que tem se dedicado nesse sentido, assim como diretamente nas nossas paróquias há uma atenção muito grande nesse sentido.
RCR – As questões sociais e mundo do trabalho têm interferido na vivência de fé das pessoas?
D. João – Essa é a mudança do mundo. Antes o ritmo de trabalho era de segunda a sexta e no fim de semana as pessoas ficavam em casa para a família e filhos. Hoje as pessoas precisam trabalhar, até mesmo em horários que dificultam a participação. Por isso mudou um pouco essa concepção. Mas o importante é que a pessoa vá até a Igreja, participe das celebrações. Estamos com a campanha “Domingo, Dia do Senhor” como um lembrete de que esse é um compromisso de todo batizado e que tenha esse período para rezar. É um momento de pausa necessária para agradecer a Deus por tudo o que vivemos. Temos possibilitado atendimento em nossas paróquias em horários especiais. Um dos exemplos é a Paróquia São Cristóvão, em Toledo, que oferece uma missa ao meio-dia para
atender aquelas pessoas que estão no trabalho e não retornam para casa no intervalo. A Igreja acabou oferecendo esse horário mais adequado às necessidades das pessoas. Outras paróquias têm missa às 6h30, antes do expediente. É uma mudança necessária para acompanhar aquilo que as pessoas estão precisando.




RCR – Mesmo com seu perfil discreto de governo na Diocese, isso não impede que muitas atividades sejam realizadas. A vida diocesana vai acontecendo e muita coisa tem saído da dormência. O que poderia elencar?
D. João – Lembramos da Cáritas Diocesana – que teve um primeiro momento de atuação ainda no final da década de 1960, a Pastoral da Saúde – que havia um núcleo pequeno em única paróquia e que agora vem com um serviço diocesano mais organizado e sistematizado, bem como a Pastoral da Comunicação reativada, além do Movimento Mães que Oram pelos Filhos com decreto de reconhecimento. E é claro, os Planos da Ação Evangelizadora que estimularam outras iniciativas pela evangelização das pessoas e de forma mais intensa no vínculo com o Regional Sul 2. Positivamente houve abertura para
essas pastorais e demais iniciativas despertarem. Nós temos o Auxílio Fraterno com um atendimento próprio e agora vem a Cáritas que abrange outros caminhos que visam a recuperação da dignidade humana. Temos esse caráter de abrir um pouco esses avanços que nos colocam no sentido mais integrado com a Igreja no Paraná e no Brasil.
RCR – Vamos falar sobre a expansão da Casa de Maria. Ela chegou em Marechal Cândido Rondon. Vem uma nova unidade por aí?
D. João – A Casa de Maria é uma mostra de que a Igreja e sociedade devem trabalhar conjuntamente em prol de crianças e adolescentes. Em Marechal Cândido Rondon, demos um grande passo na caminhada de motivação e parceria entre Igreja e sociedade que reconhecem um projeto já testado e aprovado há 30 anos em Toledo. O projeto em Marechal Cândido Rondon tem dado muito certo, com o envolvimento da comunidade de fé, paróquias, sociedade civil e poder público. Não queremos instalar algo já pronto, mas que verdadeiramente expresse o desejo da sociedade, sabendo que ela também pode participar diretamente,
se envolvendo e se responsabilizando. E agora começa a se pensar uma Casa de Maria em Assis Chateaubriand. Já ocorreu uma primeira conversa com prefeitura e paróquias para pensar nesse atendimento. É uma forma de aproveitar o conhecimento e organização da Casa de Maria de Toledo e oferecer o atendimento a essa faixa de idade que contempla crianças e adolescentes em contraturno escolar. Mas lembramos que o ponto central é a mobilização dos leigos.
RCR – Como D. João se sente sendo bispo de Toledo?

D. João – Eu me sinto bem de ser bispo daqui com meu jeito de ser, não de grandes movimentações, mas fazendo uma caminhada conjunta com as pessoas, dando liberdade e criatividade para que padres possam exercer seu ministério e com a participação dos leigos nos Conselhos de Pastoral das paróquias ou comunidades e nas pastorais e movimentos. Isso é fundamental: o leigo perceber que a Igreja não é do bispo ou dos padres, mas a Igreja é de cada batizado. Percebo que consigo realizar minha presença na Diocese de Toledo exercendo com serenidade essa missão.

A Diocese de Toledo está prestes a realizar um evento que promete iluminar o caminho da comunicação na Igreja e na vida cotidiana. O 1º Mutirão de Comunicação (Muticom) com o tema “Comunicar é dom e compromisso” é uma iniciativa da Pastoral da Comunicação que visa enriquecer e capacitar agentes que atuam na área e interessados em geral.

Com uma proposta inclusiva, o evento busca reunir leigos, tanto aqueles com experiência prévia em comunicação quanto os que estão dando os primeiros passos nesse serviço eclesial. A programação abrange duas conferências e três oficinas práticas, com temas que permeiam a espiritualidade no trabalho da Pascom e a importância da comunicação assertiva na Igreja.

As oficinas práticas são oportunidades valiosas para os participantes desenvolverem habilidades concretas. Elas incluem:
1) Comunicação assertiva a serviço da Igreja/ Prática de texto para agentes da Pascom: Nesta oficina, os participantes aprenderão a arte da comunicação eficaz e como aplicá-la em seu serviço à Igreja. A prática de redação de textos específicos para a Pastoral da Comunicação será um destaque, permitindo que os agentes aprimorem suas habilidades na criação de conteúdo relevante e inspirador.
2) Prática de Fotografia para o trabalho pastoral: A fotografia desempenha um
papel crucial na comunicação visual. Nesta oficina, os participantes serão orientados sobre técnicas de fotografia que podem ser aplicadas em seu trabalho pastoral. A captura de momentos significativos e a criação de imagens que transmitam mensagens poderosas serão abordadas.
3) Planejamento e estratégia de conteúdo para o Instagram: As redes sociais são um meio poderoso de comunicação nos dias de hoje. Nesta oficina, os participantes aprenderão a criar planos estratégicos de conteúdo específicos para o Instagram, aproveitando a plataforma para alcançar e envolver a comunidade de maneira eficaz.
O evento contará com a presença de conferencistas experientes no campo da comunicação eclesial. O Pe. Vanderlei Ghelere, pároco da Paróquia Nossa Senhora das Graças (Novo Sarandi) e pároco da Paróquia Nossa Senhora de Fátima (Vila Nova), dividirá sua sabedoria com os participantes. Além disso, o Pe. Adilson Naruishi, assessor da Pascom no Regional Sul 2 (Igreja no Paraná), compartilhará seu conhecimento e experiência.
O 1º Muticom da Diocese de Toledo está agendado para o dia 21 de outubro, das 14h às 20h, e será realizado no Instituto São João Paulo II, em Toledo. Uma oportunidade única para aprender, compartilhar e crescer na área da comunicação eclesial e, mais importante ainda, para refletir sobre como a comunicação pode ser um dom e um compromisso em nossas vidas.
Esteja preparado para uma jornada de aprendizado, inspiração e crescimento no 1º Mutirão de Comunicação da Diocese de Toledo. Comunicar é realmente um dom e um compromisso que pode iluminar nosso caminho e unir nossas comunidades.

No mês de setembro concluíram-se as reuniões do Conselho Ampliado de Pastoral na Diocese de Toledo. Este importante organismo tem como principal objetivo ajudar as comunidades paroquiais a planejar seu plano de ação pastoral, a partir das definições da Assembleia Diocesana, e monitorar essas ações no seu desenvolvimento.
Esta metodologia pastoral já é usada na Diocese de Toledo há alguns anos e tem trazido bons resultados. São duas reuniões ao longo do ano, previstas para este Conselho, descentralizadas por Decanato. A primeira delas aconteceu nos meses de março e abril e se destinou a esmiuçar as definições e prioridades diocesanas 2023 fazendo com que as comunidades paroquiais, representadas no Conselho por seus padres, representantes do CPP
 Reuniões dos conselhos ampliados de Pastoral contribuem para a caminhada diocesana
Reuniões dos conselhos ampliados de Pastoral contribuem para a caminhada diocesana
e coordenadores das pastorais e movimentos eclesiais, pudessem estruturar as ações práticas para tornar concretos os objetivos diocesanos.
Como já se sabe, 2023 é um ano dedicado prioritariamente à Animação Litúrgica, com foco na Santa Missa e na vivência do Domingo, o dia do Senhor. Além disso, a animação missionária com o compromisso de colocar o leigo batizado no foco da autocompreensão como agente evangelizador.
Depois da primeira rodada, totalmente voltada para o planejamento, as reuniões acontecidas recentemente, e concluídas no mês passado, tiveram como objetivo a avaliação daquilo que cada comunidade havia proposto. Foi motivado um momento de partilha exercitando a escuta pastoral tão valorizada e pedida pelo Sínodo dos bispos. Cada paróquia pôde partilhar os avanços e ganhos na evangelização, bem como aquilo que ainda não foi possível concluir, haja visto que temos um período considerável ainda até que o ano termine.
Além de promover a partilha pastoral, a segunda reunião do Conselho Ampliado teve também o objetivo de dar início à preparação da Assembleia Diocesana da Ação Evangelizadora, que neste ano acontece em 05 de novembro. É importante destacar que a Assembleia é o momento pastoral mais importante do ano em uma diocese. No caso de Toledo, onde são levantadas as prioridades na evangelização para o ano seguinte. Pe. André Mendes, coordenador diocesano da Ação Evangelizadora, replicou aos presentes nos quatro decanatos a orientação dos bispos do Brasil para que não se definam novas Diretrizes para a Ação Evangeli-




zadora neste momento, como o previsto originalmente para este ano. “As atuais Diretrizes para o quadriênio que estamos vivendo (2019-2023) foram concebidas a partir do texto de Atos dos Apóstolos (2,42), traduzido criativamente com a imagem da casa com seus 4 pilares (Pão, Palavra, Missão e Caridade), colocando a comunidade eclesial missionária como núcleo central da evangelização”, lembra. Na 59ª Assembleia Geral da CNBB, em agosto de 2022, ao ponderar a relevância das indicações que surgirão do Sínodo de 2023/2024, os bispos brasileiros definiram que a nova redação das Diretrizes seja aprovada e publicada em 2025. Com isso, há indicação de que 2024 seja aproveitado para robustecer projetos já iniciados e que podem render melhores frutos como é o caso do aspecto da diocesaneidade e sinodalidade da Igreja, a evangelização das famílias e das juventudes e a Iniciação à Vida Cristã.
A partir das indicações da CNBB, os
presentes nos Conselhos dentro dos decanatos apresentaram pontos de destaque e pontos de atenção na evangelização numa dinâmica de trabalho em grupo. Essas contribuições serão agora contempladas por uma comissão convocada pelo bispo diocesano. Comissão esta que tem como tarefa sistematizar as ideias e oferecer à Assembleia Diocesana, no próximo mês de novembro, um panorama das contribuições e quais os maiores desafios para o futuro apontados pelas lideranças nesta fase concluída de escuta.


A coordenação Diocesana da Animação Bíblico-Catequética da Diocese de Toledo, em sintonia com o Regional Sul 2, está apresentando as conclusões dos estudos e reflexões em vista da instituição do Ministério Laical de Catequista. O assunto pautou o Encontro Diocesano para Coordenadores Paroquiais de Catequese, em setembro.

A Animação Bíblico-catequética trabalha na perspectiva de abrir, em 2024, a 1ª turma de formação para catequistas já atuantes, que atendam aos critérios requiridos à missão de Ministro da Catequese. A partir dos “Critérios e Itinerários para a Instituição do Ministério de Catequista”, conforme Documento 112 da CNBB, a equipe diocesana prossegue em fase de elaboração do projeto para a formação imediata, com mínimo seis meses, para catequistas já atuantes. Além dos critérios do Documento 112, a Diocese de Toledo incluirá a necessidade de participação na Escola Catequética Companheiros de Emaús.
Quanto a formação para catequistas iniciantes em vista do Ministério não haverá programação diocesana para o ano de 2024. Portanto, cada coordenação paroquial de Catequese continue com as ações de acolhida e capacitação de novos catequistas enquanto não receberem novas instruções diocesanas”, informam em nota conjunta o assessor diocesano Pe. Roberto Lopes de Souza
e o coordenador diocesano Fernando da Rocha.
No entanto, a coordenação diocesana articulará a Pastoral de Animação Vocacional tendo em vista a projeção de formação aos catequistas iniciantes. Para isso acontecer, as coordenações paroquiais de Catequese terão algumas tarefas.
Ainda este ano de 2023, deverá ser realizado o cadastro de todos os catequistas, com prazo até dia 18 deste mês
de outubro. O modelo de cadastro será encaminhado pela secretaria diocesana da Catequese. Feito o cadastro, a coordenação paroquial aguarda novas instruções da coordenação diocesana.
Para novembro, tendo as fichas de seus catequistas preenchidas e em mãos, a coordenação paroquial responderá um formulário eletrônico até o dia 16 de novembro, cujo link de acesso será enviado nos grupos de WhatsApp dos coordenadores paroquiais dos Decanatos.
Estudo do Documento 112 “Critérios e Itinerários para a Instituição do Ministério de Catequista”: As coordenações paroquiais de Catequese são incentivadas a promover estudo do Documento 112 junto a seus catequistas até dezembro deste ano de 2023, no intuito de aproximá-los dos passos que a Igreja e a Diocese vêm dando em vista do Ministério de Catequista. O documento pode ser estudado em pequenos ou grandes grupos, por temáticas ou oficinas. Sempre reserve espaço para partilha e apontamentos de dúvidas.
Previsão das etapas da Escola em 2024 para catequistas já atuantes:
abril, maio, junho, julho, agosto e setembro. Em outubro, prevista a missa do mandato que será presidida pelo bispo diocesano. Esta previsão está sujeita a alterações, pois o projeto desta escola imediata ainda não está concluído. Esta escola possuirá o itinerário do caminho de Inspiração Catecumenal.
Atividade em 2 de dezembro de 2023: Memoramos a convocação para o encontro Diocesano de Coordenadores Paroquiais e Decanais de Catequese, já previsto em cronograma diocesano. Neste encontro serão atualizados os trabalhos em vista do Ministério de Catequista, projeção da Pastoral Catequética
2024








Está praticamente em conclusão, o Ano Vocacional da Igreja Católica no Brasil. Muitas experiências marcam este período em que a Diocese de Toledo se empenha com atividades e demais iniciativas visando o despertar vocacional. O Ano Vocacional será concluído em novembro. Mas até lá, uma nova experiência deste tempo favorável chega da Paróquia Nossa Senhora de Fátima, de Maripá, onde se realizaram entrevistas com pessoas que representassem as vocações: sacerdotal, religiosa, familiar e leiga. Assim, o primeiro entrevistado foi o Frei Gabriel de Moura Lima, padre religioso da Congregação dos Frades Menores Missionários; a segunda entrevista foi realizada com o casal Sandra e Gilberto, responsável pela Pastoral Vocacional; e, por último, com a coordenadora da catequese Margarete Becker.

Frei Gabriel revelou que sempre sentiu uma inclinação para as coisas da Igreja, sendo que reconheceu a sua vocação aos nove anos de idade, e em 1988 iniciou sua caminhada com os Frades Menores Missionários, em Toledo, no Paraná. Relatou que a sua vida como franciscano é composta por inúmeras bênçãos, não podendo desejar outro ofício em sua vida, cuja motivação primordial é o imensurável amor e misericórdia de Deus.
O casal Sandra e Gilberto concorda que todas as vocações são essenciais para a Igreja, sendo que cada uma se completa para a realização dos planos de Deus na comunidade cristã. A atuação do casal na Pastoral está mais focada nos

adolescentes, com ênfase na apresentação dos valores e princípios cristãos para que assim descubram o seu papel na sociedade.
Como testemunho de casal cristão, mencionaram a experiência que tiveram com a ação de Deus na recuperação da saúde de seu filho, após um acidente de trânsito. O casal não teve dúvidas ao aceitar o convite para assumir a Pastoral Vocacional, sendo um sim de amor, doação e gratidão pelas bênçãos recebidas em sua família. Como conselho para outros casais, recomendaram persistir no caminho Deus, não desanimando perante problemas e desafios, mas sim persistindo em união.
A coordenadora da Pastoral da Catequese, Margarete Becker, compartilha que Deus a capacita diariamente para exercer a sua vocação, considerando que a cada dia surgem novos desafios com o ensinamento de jovens e adultos do Município de Maripá.

Comentou que a Catequese ocorria inicialmente na casa dos catequizandos, depois foi realizada em uma escola municipal de Maripá e posteriormente no Centro Catequético.
Margarete afirma que para ser catequista é preciso muita vontade de educar na fé, com paciência e comprometimento com a vida da comunidade. Considera que a melhor forma de inspirar crianças e adolescentes atualmente é por meio do testemunho de vida de outros cristãos, de muita oração e também ao falar do Deus que criou todas as coisas e ama a todos a ponto de dar a sua vida.

A chegada das comemorações da Padroeira do Brasil e de paróquias e capelas localizadas na Diocese de Toledo faz suscitar testemunhos de milagres cuja explicação se dá pela fé em Deus. Desta vez, você conhece a experiência da Luciana Cabezas de Oliveira, da Paróquia São Roque. Ela é casada com Ademilson Ronaldo, com quem tem dois filhos: a Beatriz e o Kaio. Antes de residirem em Nova Aurora, eles moravam em Embu das Artes, na região metropolitana de São Paulo. É lá que começa esse testemunho da presença de Nossa Senhora Aparecida na vida da família.
Era um dia de chuva e Luciana cuidava dos afazeres domésticos até que se ausentou da cozinha onde estava com os filhos. Ela havia se deslocado a outro cômodo para buscar um pano e secar o chão. Foi tempo suficiente para ela ouvir um barulho de panela ao chão. Beatriz, a primogênita, que tinha 12 anos, desesperadamente levou o irmãozinho até a mãe. “Mãe caiu óleo nele. Pega, mãe”, lembra Luciana. Kaio tinha apenas oito meses de vida e estava num andador, dando os primeiros passinhos. “Comecei a tirar a blusa e na medida em que fazia isso, a pele vinha junto. Peguei ele no colo e pedi ajuda no portão de casa. Um vizinho nos levou até o pronto-socorro. O Kaio teve a primeira parada cardiorrespiratória e foi transferido para um hospital”, conta a mãe.
O pequeno Kaio foi intubado e estava sendo medicado. Na Unidade de Terapia Intensiva permaneceu por 28 dias. Nesse tempo todo, a família se pôs em oração e pediram a assistência religiosa de um sacerdote. “O Kaio permanecia imóvel até o momento em que o padre chegou. Ele levantou a mão em direção ao
padre e soltou. Eu não aguentei e saí”, lembra.
O tratamento continuou por alguns dias e Luciana se mantendo em oração. “Ajoelhei ao lado do bercinho e pedi a Nossa Senhora Aparecida para que se fosse da vontade de Deus que fizesse o melhor. Nesse momento lembro que entrou uma claridade dentro do quarto que eu não sei como explicar. Pensei: ‘tá vindo buscar’. Os aparelhos dispararam. Deixei o quarto e pensei no pior, até que a faxineira veio ao meu encontro e falou para voltar: ‘Seu filho tá te esperando’. Então eu pensei: ‘Ela deixou’”, relata.
Luciana rezava o terço todas as noites e logo após pendurava-o no berço, ao lado do bebê. Numa dessas noites, a mãe adormeceu ao lado do leito do filho até que acordou com um barulho. “Era o Kaio acordado tentando pegar o terço”, conta com brilho nos olhos. “Agradeci a Nossa Senhora naquele momento por ter
deixado nosso filho perfeito”, afirma. Passado algum tempo, Luciana fez o percurso da passarela do Santuário Nacional de Aparecida de joelhos até chegar diante da imagem de Nossa Senhora que permanece exposta na Basílica. Enquanto fazia esse trajeto, rezava o terço. “Eu falo que já acreditava muito em Deus e Nossa Senhora e esse fato aumentou levou-nos a acreditar mais e mais e recorrer sempre. Foi um milagre na nossa família”, garante.
São testemunhos como esse da família Oliveira que propagam a devoção a Nossa Senhora sob o título da Conceição Aparecida em todo o Brasil e na Diocese de Toledo não é diferente. Paróquias ou capelas dedicadas à Virgem de Aparecida estão se movimentando para as festividades que se realizam até o dia 12 deste mês, sempre pautadas pelo testemunho de pessoas simples como a Luciana que tiveram uma experiência muito próxima com Deus.

É o caso de Toledo, onde a Quase-Paróquia Nossa Senhora Aparecida, com sede no Jardim Pancera, reunirá os devotos para a Novena. Em cada noite de encontro, um tema guiará a reflexão dos participantes, sempre orientado por padres do clero diocesano.
Na primeira noite, o pastor próprio da Quase-Paróquia, Pe. Roberto Lopes de Souza, conduzirá o tema “Nossa Senhora Aparecida: intercessora dos perseguidos”, seguido de celebração eucarística com um momento devocional de oferecimento de flores à imagem da Padroeira. Os encontros da novena começarão sempre às 19h30.
Na segunda noite, a reflexão aos devotos será do tema “Nossa Senhora Aparecida: modelo de desapego”, seguida de missa sob presidência do pároco da Paróquia São Pedro e São Paulo, de Toledo, Pe. Mauro Cassimiro.
A terceira noite terá a reflexão do tema “Nossa Senhora Aparecida: Mãe dos vocacionados”, com missa presidida pelo pároco da Paróquia Sagrado Coração de Jesus, de Marechal Cândido Rondon, Pe. Sérgio Augusto Rodrigues.
A quarta noite da novena, terá o tema “Nossa Senhora Aparecida: um apelo à conversão”. Na ocasião, a missa será presidida pelo pároco da Paróquia São Cristóvão, de Toledo, Pe. Luiz Carlos Franzener.
A quinta noite da novena, que será num sábado, contará com o tema “Nossa Senhora Aparecida: a Senhora do Rosário”. Pe. Roberto presidirá a celebração e logo após acontecerá a “Noite do Pastel” para confraternização dos devotos.
No domingo, dia 8, que será o 6º dia
da Novena, às 19h30, o tema conduzirá a reflexão dos devotos para a comemoração da data que será “Nossa Senhora Aparecida: intercessora dos nascituros e das mulheres grávidas”. O Dia do Nascituro (8/10) é celebrado pela Igreja Católica no Brasil como proposta de conscientização dos fiéis sobre o direito da vida nascente, o feto que está em gestação, e contra o aborto. Nesta noite da novena, durante a missa, Pe. Marcos Denck da Silva, que é pároco na Paróquia Santa Rita de Cássia, de Toledo, estará no Jardim Pancera para a bênção das mulheres grávidas e dos nascituros. Logo após, haverá confraternização na comunidade.

Por fim, nos dias 9, 10 e 11, mantendo o horário das 19h30, as reflexões propostas serão com os temas, em sequência: “Nossa Senhora Aparecida: Mãe de Misericórdia”, com bênção dos trabalhadores da festa; “Nossa Senhora Aparecida: Mãe do silêncio
e da hospitalidade”, com bênção das chaves; e “Nossa Senhora Aparecida: intercessora dos pecadores”, com bênção da saúde. Respectivamente presidirão as celebrações destas noites: Pe. Roberto Lopes de Souza; Pe. André Fatega, da Paróquia Sagrada Família, de Toledo; e Pe. Juarez Pereira de Oliveira, reitor do Seminário Maria Mãe da Igreja.
A celebração da Padroeira, em 12 de outubro, contará com procissão às 9h, saindo da Capela Imaculada Conceição, localizada no Jardim Filadélfia. Em um trajeto curto, de aproximadamente um quilômetro, os devotos seguirão cantando e rezando até chegar na Igreja Matriz, onde haverá missa às 10h, seguida de almoço festivo, tendo no cardápio costela e frango assados, com acompanhamentos. Informações na secretaria da Matriz.
Por sua vez, os católicos de Ouro Verde do Oeste que organizaram a programação religiosa e festiva para celebrar a Padroeira tem uma novidade.
Com o apoio de toda comunidade, especialmente de devotos, as comemorações seguem ritmo intenso desde 8 de setembro, quando teve início o roteiro de visitas da imagem peregrina às capelas. Nestas visitas, a imagem de Nossa Senhora reuniu os filhos devotos para rezar o memorial da Salvação que Jesus comunicou.
Agora, em outubro, a movimentação dos devotos ouroverdenses se dá com o início da Novena de Nossa Senhora Aparecida. A partir do dia 3, o terço será rezado às 19h na Igreja Matriz, seguido de celebração eucarística.
Mais adiante, no dia 7, está programada a ação entre amigos, com a realização da chamada “Quermesse da
Padroeira”, na Praça Central. A atividade começará às 18h30, com o terço, segui-
A Festa da Padroeira, na cidade de Mercedes, contará com a peregrinação da imagem de Nossa Senhora às capelas, tendo sido iniciada ainda em setembro. No decorrer de outubro, a programação é a seguinte, sempre com missa: dia 1º, devotos da Capela São Luiz recebem a imagem às 10h; dia 2 – Capela Bela Vista recebe a imagem às 19h30; dia

3 – Capela Porto Mendes recebe a imagem às 19h30; dia 4 – Capela Cunhaporã recebe às 19h30; dia
5 – Capela São Marcos recebe a imagem às 19h30; dia 6 – Capela Três Irmãs recebe a imagem às 19h30; dia 7 – Capela Arroio Guaçu recebe a imagem às 15h. No dia 8 de outubro, a concentração de devotos em Mercedes acontecerá na rotatória, saída para Três Irmãs, quando haverá a acolhida da imagem de Nossa Senhora às 9h30. Deste local, os devotos seguirão em procissão até a Igreja Matriz para a missa às 10h.
Logo após, haverá almoço de con-
fraternização com o tradicional frango recheado, churrasco suíno e bovino, e demais acompanhamentos. A partir das 13h30, haverá leilão de animais e ação entre amigos. Às 15h, matinê.
Em Guaíra, a novena da Padroeira será de 2 a 10 deste mês de outubro, sempre às 19h30, sendo que no dia 7, após a celebração, haverá a confraternização “Noite dos salgados” no pátio

do de missa.
Com o calendário avançando, o Tríduo de Nossa Senhora Aparecida dará sequência às festividades religiosas. Nos dias 9, 10 e 11, haverá celebração eucarística às 19h com bênção especial para as crianças e famílias.
A novidade inserida na programação deste ano é a cavalgada de devotos. Ela será no dia 12, com saída às 16h desde a Capela Bom Jesus – Linha Cerâmica, que seguirá em procissão até a Igreja Matriz. A comissão organizadora prepara uma bonita recepção da imagem peregrina pelos devotos que já estarão reunidos para a celebração solene marcada para começar às 19h30. Na celebração, acontecerá o momento devocional com a coroação da imagem da Padroeira e testemunhos de bênçãos e graças alcançadas por intercessão de Nossa Senhora Aparecida junto a Jesus.
do Salão Frei Angélico. Já no dia 11, um momento marcante, que é tradicional, reunirá os fiéis das duas Paróquias de Guaíra. Às 19h, eles sairão em procissão da Igreja Nossa Senhora dos Navegantes com destino à Igreja Nossa Senhora Aparecida, num trajeto de aproximadamente 1.600 metros. No dia 12, Dia da Padroeira, às 9h, a missa com solenidade de coroação de Nossa Senhora Aparecida e consagração dos devotos. Para o almoço, haverá o tradicional churrasco e ação entre amigos.
Em Terra Roxa, os devotos participarão da novena a partir do dia 3, com visitação da imagem da Padroeira nas comunidades da Paróquia, contemplando temas específicos para a reflexão. A comissão organizadora preparou ainda a festa com almoço de confraternização.





O cuidado e atenção com os filhos se expressa de muitas maneiras, e uma delas acontece por meio da oração. Toledo agora conta com o grupo “Mães Mônica – Mães que rezam pelos filhos”, incentivado pelos freis da Ordem dos Agostinianos Descalços, que mantém seminário na cidade.
O grupo Mães Mônica é formado
por 77 mães, subdividido em células chamadas de “coros”, cada uma com sete mães. Assim, cada dia da semana, uma mãe reza pelos seus próprios filhos e pelos filhos das outras mães que fazem parte deste coro, onde cada um é nominado na oração. A inspiração é de Santa Mônica, que rezou tantos anos pelo filho Agos -
tinho, hoje santo da Igreja Católica Apostólica Romana.
No dia da Padroeira, as mães participaram da celebração eucarística com a entronização das capelinhas. Na mesma ação de graças, participaram as integrantes da Associação de Oficinas de Caridade Santa Rita de Cássia.









Neste dia 8 de outubro, será realizada a tradicional festa da Paróquia Menino Deus, de Toledo. A cada ano se realiza em todas as capelas e setores da comunidade, em preparação da festa, Missas com a visita do Menino Deus. É um momento bonito de oração e celebração em que as famílias expressam sua fé no Menino Deus.

Neste ano, os fiéis se reúnem em torno do tema “Menino Deus e o domingo, dia do Senhor”, e do lema “Ouve, ó Israel; o Senhor, nosso Deus, é o único Senhor” (Dt 6,4). O pároco, Pe. Geraldo Marino Ferreira, explica a escolha do tema e lema. “Estamos conscientizando os fiéis que, como cristãos católicos, somos chamados a cultivar nossas tradições religiosas, como participar das missas nos domingos e festas de guarda, pois o domingo é o dia do Senhor. Isso quer dizer que no domingo, dia da ressurreição do Senhor Jesus, não podemos deixar de participar das missas ou celebração da Palavra (cultos), celebrando assim nossa fé na Palavra de Deus que ilumina a vida do povo, e na Eucaristia, sustento e fonte de vida do povo de Deus”, salienta. Na preparação da Festa, os fiéis receberam em suas comunidades a visita da imagem do Menino Deus, em
sinal de unidade paroquial.
Agora, nos dias que antecedem a Festa, acontece a novena do Padroeiro na Igreja Matriz, localizada no Jardim Porto Alegre. Em cada noite, além da reflexão proposta, serão realizadas as bênçãos
especiais aos participantes.
“Queremos desde já agradecer todas as equipes de trabalhos, pastorais, movimentos e Conselho Administrativo das comunidades que trabalham há vários meses para acolher da melhor forma possível todas as pessoas e famílias que neste momento se preparam para confraternizar conosco. Queremos agradecer também todas as famílias e empresas patrocinadoras de nossa festa. Que o Menino Deus seja fonte de bênçãos a todos”, destaca Pe. Geraldo.
Para o grande dia celebrativo e festivo, 8 de outubro, a expectativa é reunir milhares de pessoas. Para tanto, a acolhida aos fiéis se dará na missa, às 9h30, ocasião em que serão recebidas as representações das comunidades que formam a Paróquia com os respectivos padroeiros. Durante a celebração, será realizado o rito de bênção das famílias. Logo em seguida, o almoço de confraternização será servido àqueles que fizeram aquisição antecipada dos kits. A festa popular reserva ainda a apresentação dos reis e rainhas das comunidades (14h), ação entre amigos dos dizimistas (14h30) e resultado da ação entre amigos (16h). Para concluir, haverá matinê às 16h30.
A novena teve início em setembro com as bênçãos especiais para cada dia, tendo sido já realizadas com a bênção das fotos que representam vocações (Matrimônio, sacerdotal, religiosa e serviços à comunidade) e das fotos de batizados, bem como realizada a renovação das promessas do Batismo. Com a proximidade da Festa do Padroeiro, a programação é a seguinte:
Dia 1º, às 7h30 e às 19h - 3º dia da novena: Menino Deus e o domingo, dia do Senhor.
Bênção dos pães
Dia 2, às19h30 - 4º dia da novena: Menino Deus e a família que reza unida; Bênção das fotos de famílias.

Dia 3, às 19h30 - 5º dia da novena: Menino Deus e a educação na fé dos filhos; Bênção das fotos de filhos









Dia 4, às 19h30 - 6º dia da novena: Menino Deus e a devoção a Nossa Senhora; Bênção

dos objetos, da saúde e das equipes de trabalho da festa.
Dia 5, às 19h30 - 7º dia da novena: Menino Deus e a oração do terço – Bênção das imagens de Nossa Senhora e do terço.
Dia 6, às 19h30 - 8º dia da novena: Menino Deus e a comunidade de fé – compromisso e missão – Bênção dos objetos de trabalho.
Dia 7, às 19h - 9º dia da novena: Menino Deus e a vida, dom de Deus (dia do nascituro) – Bênção das grávidas e das crianças.
As comemorações por ocasião dos 50 anos da Pastoral da Juventude no Brasil reuniram mais de 5 mil jovens no Santuário Nacional de Aparecida (SP). A Diocese de Toledo esteve presente com uma caravana de pejoteiros, como são chamados aqueles que integram a Pastoral da Juventude.

Nesta festa jubilar histórica, realizada em 9 de setembro último, os participantes fizeram memória da trajetória da Pastoral e celebraram juntos, com muita mística, espiritualidade e animação. Houve ainda várias apresentações musicais e teatrais que lembraram o solo sagrado do grupo de jovens e outras vivências comunitárias.
Papa Francisco enviou uma carta parabenizando pelos 50 anos de história da PJ no Brasil. “Exorto-os a seguirem em frente com a coragem, a ousadia e a criatividade que lhes são característicos, sem desanimar nem deixar que lhes roubem a esperança”, escreveu o Pontífice.
O serviço eclesial de acompanhamento da juventude passa pela constante formação. Com essa finalidade foi realizada dias 2 e 3 de setembro, a 3ª etapa da Escola Diocesana de Lideranças (EDL), mantida pela Pastoral da Juventude. A etapa foi abrigada no Seminário Santa Mônica, em Toledo, e contou com a presença de jovens de grupos de base da Diocese. A programação teve como assessores Lígia Dalastra, Rosenildo dos Santos, Cleyton Silva e Marinês Bettega.



A coordenação da Pastoral da Juventude, do Decanato Assis, promoveu nos dias 26 e 27 de agosto último, na Chácara Dois Irmãos da cidade de Assis Chateubriand, a 4º Edição do Acampamento Kairós. Em dois dias de formação e espiritualidade, os participantes se reuniram em torno do tema “Esse é o nosso chão, essa é a nossa cara”. Segundo os organizadores, o Acampamento contou com a presença dos grupos de
base do Decanato. Na assessoria estiveram Cleyton Silva, Cleberson Pereira e Viviane. Coube à Karol Borges e Kaliny Cruz conduzir o momento de mística da PJ. O Pe. Leonardo Ribeiro de Souza Castro presidiu a Santa Missa no local. “O acampamento foi uma bênção e graças a Deus atingimos o objetivo que era mostrar o rosto da PJ para os nossos jovens”, comenta Flavia Barbosa, coordenadora diocesana da PJ.
Em média uma criança passa de cinco a oito horas no espaço escolar. É neste ambiente que irá ampliar seus vínculos, aprender a conviver com uma comunidade, para além da família e, consequentemente, com as diferenças inerentes a esta relação. Vai trilhar caminhos de aprendizados e será desafiada pelos múltiplos saberes. Assim, escolher a escola é uma decisão que implicará no futuro da criança.
Cada vez mais, a escola deve promover o fortalecimento da inteligência emocional, da saúde psicossocial e a construção de relações saudáveis. “É preciso compreender que estas são as bases para o aprendizado cognitivo e socioemocional. Quanto mais o ambiente oferecer experiências relacionadas à inteligência emocional, mais ela está aberta para o aprendizado científico. A felicidade e o bem-estar são fundamentais para o desenvolvimento de um ser humano”, explica o Psicólogo e Diretor do Colégio La Salle, Ir. André Muller.
Para o Psicólogo e Diretor Lassalista, a estrutura física das escolas é outro fator importante a ser observado.
“Hoje, há um consenso de que precisamos promover a interação das crianças com a natureza, pelo ganho à saúde física, mas também por outros aspectos, pois a natureza oferece diversos estímulos que permitem às crianças explorarem e conhecerem o mundo ao seu redor, utilizando diversas habilidades importantes, como a criatividade, a curiosidade, a atenção, a percepção e o pensamento, entre outras funções cognitivas”.
A Pedagogia Lassalista é dedicada à formação integral dos seus estudantes, por tanto, promove um aprendizado baseado em experiências concretas com o mundo e os valores Cristãos. Conta com uma área privilegiada de natureza em abundância que favorece as melhores experiências cognitivas e socioemocionais, Além de Laboratórios de Ciência e espaço Maker, que proporcionam o aprender com a mão na massa.
As famílias interessadas em conhecer o Colégio La Salle podem visitar o espaço e conversar com os responsáveis. O Colégio já está com as matrículas abertas.

A evangelização dos ambientes é o carisma do Movimento de Cursilhos de Cristandade (MCC). Este é o propósito dos cursilhistas que, após participação em retiro de espiritualidade, aproximam-se do anúncio querigmático e lançam-se no mundo para transformá-lo pela mensagem cristã. Mas a pergunta é: o primeiro ambiente, o interior de si, já está impregnado com o amor de Cristo?


O 2º Recolores Diocesano provocou os participantes a esta reflexão. O Recolores até então era um evento realizado nos Setores do MCC para aqueles cursilhistas que estavam afastados das atividades. Porém, a partir do ano passado adquiriu caráter diocesano e deixou de ser somente para
Participantes do
no Centro de Formação Instituto São João Paulo II afastados, mas incluiu a formação, atualização e motivação para quem está no Cursilho.
Aproveitando o conhecido método “ver, julgar e agir”, Rosane Granemann, cursilhista de Rio Negro (PR), ex-coordenadora do Grupo Executivo Regional (GER), convidou os participantes a se verem como estão agindo na perspectiva cristã, assim como incentivou-os a discernir a própria vida à luz da fé, e no final, o que cada um percebe como ponto prioritário
que não está bem na caminhada de fé e de relações com a família e nos ambientes e que precisa melhorar. Foi assim que cada um escreveu de próprio punho um compromisso posteriormente apresentado ao altar, durante a missa, no momento do ofertório. Quem viveu esta experiência sentiu-se tocado na sua missão cristã. Rosane ainda conduziu outro momento em que enfatizou a formação e liderança no MCC e na Igreja na programação do evento realizado dias 2 e 3 de setembro último, no Centro de Formação Instituto São João Paulo II, em Toledo. A proposta do evento formativo foi promover a reflexão de como aplica no dia a dia esse compromisso cursilhista.
“Significou muito para mim; um resgate de algo bom que estava um pouco adormecido. Foi muito aprendizado e amor. São encontros como esse que fazem o ser humano voltar-se para Deus, assim espero viver meu 4° dia, sendo melhor e em espírito e atitude de cristão comprometido nos ambientes em que convivo: casa, família, trabalho, sociedade, e que eu possa, com a graça de Deus, seguir firme neste propósito”.
(Eduardo Antunes)
“Foi poder ver novamente que o caminho é o da nossa fé e que nem sempre esse caminho será o mais fácil ou mais legal, mas sim é o que nos levará a um resultado além do esperado momentaneamente. É continuar seguindo o caminho que Deus ajuda a trilhar, pedindo em oração a sua companhia e bênção”.
(Pietro Massocatto)
Os participantes do Recolores contaram ainda com a presença do bispo diocesano, D. João Carlos Seneme, que deu ênfase na sua mensagem sobre o tema da graça em participar da vida em Cristo. “É permitir diariamente que Jesus faça parte da vida de cada um no seu cotidiano para manter-se longe do pecado”.


O programa formativo do 2º Recolores incluiu outros importantes temas de reflexão: um olhar sobre o sentido da vida (à luz da fé, estou aqui para quê?), como administrar o tempo e se manter conectado a Cristo e “A importância do MCC na espiritualidade do 4º dia” (leia ainda
nesta reportagem o que disseram dois participantes sobre a vivência do 4º dia).
Outro momento marcante desta edição do evento foi a espiritualidade proposta a partir do serviço, representado pelo gesto do lava pés. Havia oito grupos durante o Recolores com presidente e secretários que apresentaram na plenária as sínteses das reflexões propostas. E no momento desta espiritualidade, Pe. Luiz lavou os pés de um presidente e secretário e assim estes fizeram o mesmo com cada um dos integrantes dos seus respectivos grupos. Foi uma atividade que chamou bastante a atenção.

Em ação solidária aos irmãos gaúchos atingidos pelo ciclone extratropical e enchentes, a Diocese de Toledo, por meio da Cáritas Diocesana, enviou a contribuição dos fiéis que participaram das celebrações dos dias 23 e 24 de setembro últimos em cada igreja matriz ou capela. O gesto concreto em favor destas pessoas que estão


desalojadas e precisam recompor sua rotina o mais breve possível segue o propósito de solidariedade e partilha.
O mesmo ocorreu por iniciativa dos católicos de Pato Bragado que se mobilizaram na arrecadação de produtos de limpeza e de higiene pessoal, alimentos, roupas e demais itens. A mobilização ocorreu em par-

Pascom
ceria com a Associação Bragadense de Dança. Entre tantos colaboradores nesta ação, também se envolveram catequizandos e líderes da Pastoral da Criança e da Pastoral da Pessoa Idosa. Donativos chegaram ainda de municípios vizinhos, dentre eles Marechal Cândido Rondon, Entre Rios do Oeste, Quatro Pontes, Nova Santa Rosa e Santa Helena.

A Diocese de Toledo vivenciou uma rica experiência no mês de setembro, referência para o estudo e a contemplação da Palavra de Deus. Desde 1971, o Mês da Bíblia suscita maneiras para a leitura e contemplação da Bíblia na família, círculos bíblicos, catequese, grupos de reflexão e comunidades eclesiais.
Com o lema “Vestir-se da nova humanidade” (Ef 4,24), a Carta aos Efésios foi escolhida pela Comissão da Pastoral da Animação Bíblico-Catequética da Conferência Nacional dos Bispos do Brasil (CNBB) para este ano de 2023. Com isso, numa promoção da Comissão Diocesana da Animação Bíblica, aconteceu no mês passado a Escola Bíblica tendo como tema central o estudo desta Carta. “A Carta aos Efésios oferece considerável contribuição à reflexão acerca da natureza da Igreja ao tratar da temática da unidade do corpo de Cristo, tema central deste escrito. Essa unidade é fundada na ação salvífica de Jesus Cris-
to, que reconciliou a humanidade com Deus, simbolizada pela união de dois povos antes inimigos, a saber: judeus e gentios” (Comissão Episcopal Pastoral para a Animação Bíblico-Catequética / Mês da Bíblia 2023 – Carta aos Efésios: Texto-Base. Brasília: Edições CNBB, 2023, p. 7).
Na Diocese de Toledo, foram quatro terças-feiras ao longo do mês de setembro onde os participantes tiveram a oportunidade de avançar na reflexão desde aspectos mais introdutórios, onde se frisou o contexto de escrita

da Carta até seu conteúdo específico e mensagem. A iniciativa foi coordenada pelo Pe. Luiz Carlos Franzener que ministrou duas das aulas, sendo que as demais foram conduzidas pela Bacharel em Teologia Bernadete Novaschinski e pela doutora Elenira Aparecida Cunha Moreira, especialista em Bíblia da Arquidiocese de Cascavel.
A escola é fruto de um esforço em conjunto que começou nas paróquias, onde ainda no final do mês de agosto foram distribuídos folhetos com uma proposta didática para a leitura da Carta aos Efésios, versículo a versículo, durante os 30 dias do mês de setembro. Junto da motivação para a leitura veio também o convite para o estudo bíblico, com a proposta de inteirar-se deste livro sem a necessidade de sair de casa. O estudo aconteceu de maneira remota com iteração em tempo real sendo ofertado através do canal oficial da Diocese de Toledo no Youtube.

Comunidades que contam com escolas bíblicas permanentes, como é o caso da Paróquia Santo Inácio de Loyola em Jesuítas, interromperam seu conteúdo programático para acompanhar em sintonia, a escola bíblica diocesana.
Cabe a lembrança de que a Animação Bíblica é um dos quatro pilares que sustentam o atual plano nacional da Ação Evangelizadora. Ao objetivar a fundação e fortalecimento de comunidades eclesiais missionárias, a Igreja no Brasil aposta na metodologia do aprofundamento bíblico que deve ser ofertado de maneiras criativas e de modo contínuo aos fiéis. A comissão da animação bíblica, já mencionada anteriormente, surgiu com este propósito. Além da escola bíblica diocesana outras ações foram ofertadas ao longo do mês de
setembro como os círculos bíblicos de oração, que compreendem uma metodologia orante a partir da contemplação da Palavra aproximando-a da vida das pessoas, e a maratona bíblica, atividade pensada e preparada exclusivamente para a catequese de iniciação com uma proposta lúdica para oportunizar o contato dos catequizandos com a Palavra e a curiosidade em explorar o texto escrito. A maratona bíblica, oferecida a todas as comunidades da nossa diocese, foi uma parceria com a Animação bíblico-catequética.
 1ª aula on-line da Escola Bíblica Diocesana de 2023
1ª aula on-line da Escola Bíblica Diocesana de 2023
“Este Movimento é uma grande bênção para toda a Igreja porque, certamente, vai levar muitas famílias serem restauradas”. A afirmação é do bispo referencial do Movimento Mães que Oram pelos Filhos junto à Conferência Nacional dos Bispos do Brasil, D. Mário Marquez (OFMCap), bispo da Diocese de Joaçaba – Santa Catarina, que fez questão de marcar presença no 6º Encontro Estadual do Movimento realizado no Santuário Nossa Senhora da Salette, em Braganey, Arquidiocese de Cascavel. O encontro contou com a participação de mil mães, dentre as quais, uma caravana com 155 mães da Diocese de Toledo.
A coordenadora diocesana, Neyva Martini, retornou bastante animada do evento, especialmente por conta do conteúdo apresentado na programação, que contemplou momentos formativos com temas pontuais e necessários para a perseverança das mulheres no Movimento, dentre os quais o itinerário espiritual para as mães. “O Encontro foi fantástico do começo ao fim. Contou com mais de 1.000 mães participantes”, resume.


“Para quem começou com uma meia dúzia de mulheres rezando no começo e hoje vemos tantas mães espalhadas pelo Brasil afora e outros países, percebemos que é um sinal de Deus para os tempos atuais”, acrescentou D. Mário Marquez. Para ele, o Movimento Mães que Oram pelos Filhos é uma resposta à necessidade do mundo, de forma organizada e com um carisma especial. “O Espírito Santo, de tempo em tempo, sopra e realiza as maravilhas na vida de cada um de nós. Isso mostra que devemos estar abertos à ação do Espírito Santo a todo momento”, salientou.
Na conclusão do encontro, o bispo rezou para que Nossa Senhora da Salette e Santa Mônica continuem oferecendo o referencial para que cada mãe se torne discípula e missionária de Jesus na Igreja, na família, na comunidade.


Da Diocese de Toledo, participaram caravanas das cinco Paróquias que já têm o Movimento organizado, e também do
mais novo grupo formado na Paróquia Nossa Senhora dos Navegantes, de Guaíra, que iniciou recentemente seus encontros no dia 29 de setembro último.
As amigas Marinês Bettega e Maria Fedel, da Paróquia São Cristóvão (Toledo) estão se preparando para uma experiência missionária em Angola (África), junto à missão em que atuam as Pequenas Irmãs da Sagrada Família. A previsão é de que elas embarquem em janeiro do ano que vem para três meses de vivência junto à comunidade angolana. As ações da dimensão missionária realizadas no âmbito paroquial certamente contribuíram para que estas duas mulheres estejam dispostas a buscar essa experiência de missão.


Em outubro é celebrado o Mês das Missões. Em comunhão com essa proposta, todos os anos é realizado o Dia Nacional da Juventude (DNJ). A data surgiu em 1985, Ano Internacional da Juventude (ONU) como uma atividade permanente da Conferência Nacional dos Bispos do Brasil (CNBB) que é realizada nas dioceses de todo o País.
Estava evidente que a juventude precisava mobilizar-se e construir espaços de participação, para pensar e repensar uma nova sociedade. Todos os anos organiza-se um dia de festa da juventude, sempre com um tema importante a ser debatido e trabalhado com grupos. Em sintonia com a Campanha da Fraternidade 2023, o tema deste ano é “E todos ficaram saciados”.
A realização do DNJ acontece todos os anos no último domingo do mês de outubro, exceto em ano eleitoral. Pensando nisto, a coordenação do Setor Juventude da Diocese de Toledo sugere que no dia 29 deste mês de outubro haja nas missas um comentário recordando o DNJ, com ao menos um canto que fale sobre juventude, além de uma prece direcionada aos jovens. Mas antes, espera-se grande participação dos jovens no fim de semana anterior, dia 22 de
outubro, por ocasião do Festival Vocacional (Festivo), em Quatro Pontes.
Foi produzido um material para ser estudado e efetivamente realizado nos grupos de todas as expressões juvenis da Diocese, o qual será encaminhado para as secretarias paroquiais. O material tem por base o subsídio disponibilizado pela CNBB e conta com três encontros preparatórios e roteiro, como sugestão, para realização das missões no último final de semana de outubro.
Nas paróquias onde ainda não existem grupos de jovens, é recomendado que usem o roteiro por pastorais e movimentos como oportunidade de visitas, e além do momento de oração, as famílias que quiserem poderão fazer doações de alimentos para o Auxílio Fraterno.
Acessem aqui o material do DNJ 2023
“Conta-se com a colaboração de todas as paróquias para repassar este material aos coordenadores de grupo de jovens ou aos coordenadores de Catequese e outras pastorais, para que possam direcionar o jovem nas comunidades e festejar juntos”, salienta Pe.
Para o mês de outubro, a Pastoral da Saúde da Diocese de Toledo realiza a sensibilização para o Movimento do Outubro Rosa. Outubro é um mês especial para as mulheres, é o mês de sensibilizar para o Movimento Outubro Rosa, com o objetivo de conscientizar sobre a importância da prevenção ao Câncer de Mama, doença mais comum entre as mulheres do mundo todo.
Também propõe que as Paróquias promovam uma Celebração Eucarística, alusiva ao Dia do Médico (18/10), com objetivo de propiciar não só ao profissional médico, mas a todos os profissionais que compõem as equipes de saúde e comungam da fé católica, para participar da celebração e receber uma bênção especial.


No dia 26 deste mês de outubro, completaremos dois meses do retorno do cardeal Geraldo Majella Agnelo à morada do Pai. A edição nº 295 da Revista Cristo Rei já se encontrava para impressão em gráfica quando chegou a notícia de sua partida, após um longo período de saúde debilitada em consequência de um Acidente Vascular Cerebral (AVC).
Arcebispo emérito de São Salvador (BA), D. Geraldo foi o 2º bispo da Diocese de Toledo. Além de seu pastoreio, deixou uma profunda marca histórica para a cidade de Toledo na decisiva atuação, conjuntamente com lideranças locais, pela inauguração do ensino superior em Toledo, através dos primeiros cursos de Filosofia e Ciências Econômicas na então Faculdade de Ciências Humanas Arnaldo Busato, hoje Unioeste.
No dia 19 deste mês de outubro, D. Geraldo Majella Agnelo completaria 90 anos. Muitos leigos sentiram sua páscoa definitiva, porém manifestaram profundamente carinho e admiração. Lidia Mara comentou nas redes sociais da Revista Cristo Rei que o conheceu pessoalmente e que “o Cardeal era muito humano”. Devanir Padovan revelou que recebeu o Sacramento da Crisma com rito administrado por D. Geraldo, e Valdeci Conrat o primeiro mandato de
Ministro Auxiliar da Comunidade. Por sua vez, Celso Gibbert manifestou: “Recordo com carinho dos tempos que esteve em Toledo”. Egon Portz escreveu a respeito de D. Geraldo: “Uma pessoa inteligente, verdadeiro discípulo de Cristo. Que Deus o recompense por tudo”!
Enquanto residiu em Toledo, D. Geraldo era reconhecido entre o clero como um bispo com lógica de Igreja muito clara e precisa. Além disso, sempre foi amigo, de fácil acesso e muito simples.
Após ter sido feito Cardeal, D. Geraldo
participou de dois conclaves, sendo em 2005, que elegeu o Papa Bento XVI, e em 2013 quando foi eleito Papa Francisco. Ele foi um dos três presidentes da Conferência Geral do Episcopado Latino-americano e do Caribe realizada em Aparecida (SP), em maio de 2007.

D. Geraldo tinha o lema episcopal “Caridade com fé”. Em seu governo na Diocese de Toledo inaugurou em maio de 1979 o Seminário Maria Mãe da Igreja. Criou em 1980 a Paróquia Cristo Rei, em Entre Rios do Oeste.

A Pastoral da Pessoa Idosa (PPI), que é um serviço da Igreja dedicado à valorização integral deste público, através da promoção humana e espiritual, segue em busca de conhecimento para aprimorar sua atuação. Líderes do Decanato Toledo marcaram presença em recente encontro promovido pela 20ª Regional de Saúde que teve por objetivo o debate acerca do cuidado e atenção às pessoas acima de 60 anos. No evento, participaram coordenadores e representantes da Atenção Primária de municípios
Líderes
da região que atendem idosos pelo Sistema Único de Saúde (SUS), dentre eles servidores de Unidades Básicas de
Saúde, profissionais da enfermagem e medicina.
Com a presença da Pastoral da Pessoa Idosa em eventos como este que privilegiam a linha de cuidado à saúde da pessoa idosa, é possível estabelecer relações com as entidades e órgãos governamentais pelo bem dos seus atendidos. A interação com órgãos governamentais é fundamental no trabalho das líderes da PPI que passam a conhecer de maneira mais próxima quais são as estratégias de educação e promoção da saúde do idoso.
























Outubro chega com as atenções voltadas para a realização do Festival Vocacional (Festivo) da Diocese de Toledo, atividade integrante das comemorações do 3º Ano Vocacional, motivado pela Igreja no Brasil. Cercado das melhores expectativas, o Festival oferece ao público oração, descontração, muita música e convivência fraterna para estimular a cultura de vocações.
O ambiente que recepciona a grandeza desse evento neste dia 22 de outubro é o Seminário São Cura d’Ars, de Quatro Pontes. A partir das 14h30, muita animação para receber os participantes do evento, sejam eles grupos que estarão se apresentando ou plateia. A proposta do Festivo é que ele seja bem dinâmico, pois conforme as regras, cada apresentação não passará de seis minutos. Os participantes receberão um troféu por apresentação, seja ela musical ou de dança em grupo. As inscrições dos interessados em participar vão até dia 10. Informações no
Whatsapp (45) 3277-1186.
Enquanto se realizam as apresentações, a novidade do evento é a exposição que acontecerá na Tenda dos Carismas, formada pelas congregações religiosas que poderão expor um pouco das suas atividades, dentre elas, missionárias. É uma forma de divulgar as
Neste ano, a Semana Nacional da Vida (1º a 7/10) tem como proposta de reflexão o tema “Adoção: amor com laços do coração”. No período, são promovidas diversas atividades em todo o País, a partir da criatividade pastoral e da realidade de grupos, famílias e comunidades.
A Pastoral Familiar Nacional dispõe de um subsídio próprio para a para a Semana Nacional da Vida. Também são oferecidos sete roteiros para os encontros de reflexão pautados nos temas: “Adoção: um projeto de Deus”; “Adoção: alargar
Adoção é uma possibilidade de abertura do casal para a vida os vínculos da carne e do sangue”; “O amor que adota é dom de si”; “Adoção é uma forma de caridade”; “Adoção, gesto concreto em favor da vida”; “Adoção, a fecundidade do amor” e “A adoção
congregações e despertar o interesse do público infanto-juvenil para a vida consagrada. Além da exposição dos carismas das casas religiosas, também as pastorais e movimentos vão expor os seus trabalhos, através de workshops.

O Festival Vocacional contará ainda com testemunhos vocacionais e será concluído com a Missa, às 18h30, sob presidência do bispo diocesano, D. João Carlos Seneme.
No período do Ano Vocacional, a Diocese de Toledo contou com atividades harmônicas nas paróquias para a promoção das vocações. Por meio da Missão Vocacional, crianças, adolescentes e jovens foram impactados, à luz do cristianismo, por conteúdos necessários na existência humana. Religiosas e religiosos, padres e leigos se dedicaram intensamente nesse propósito. “Pela graça de Deus esperamos que este trabalho produza inúmeros frutos para a Igreja”, estima o articulador do Ano Vocacional 2023, Pe. Juarez Pereira de Oliveira.
Aponte a câmera do seu telefone celular para o QR Code e assista a entrevista com a assistente social Rita Adria Ruiz, integrante do Grupo de Apoio à Adoção de Toledo, na Voz da Diocese de Toledo. Conheça a realidade da adoção na região diocesana.
enriquece a família”.
Ao final, o material contém a sugestão para celebrar o Dia do Nascituro, em 8 de outubro, com o tema “Direito de nascer e ser acolhido em uma família”.



O tema do 18º Congresso Diocesano do Apostolado da Oração e Movimento Eucarístico Jovem (MEJ) – “Nossa vocação toca o coração e se faz missão” – deixou muito claro o compromisso do cristão. Com reflexões que contemplaram o Ano Vocacional, a sinodalidade e a missionariedade, os participantes do evento retornaram aos seus lares ainda mais motivados pela programação desenvolvida. Além dos adultos, os jovens participaram do congresso, sinalizando que é possível inspirar outros mais para a devoção ao Sagrado Coração de Jesus. O bispo diocesano, D. João Carlos Seneme, presidiu a celebração eucarística. Pe. Luiz Carlos Franzener, assessor diocesano do Apostolado da Oração e MEJ, enalteceu o esforço de cada participante do Congresso e reforçou o pedido para que sigam convictos da caminhada, rezando sempre a oração: “Jesus manso e humilde de Coração, fazei o nosso coração semelhante ao vosso”.









27º Domingo do Tempo Comum | 8 de outubro de 2023
Leituras: Is 5,1-7; Sl 79(80),9.12.13-14.15-16.19-20; Fl 4,6-9; Mt 21,33-43
Os textos bíblicos apresentam metáforas, poesias e parábolas para nos ensinar como Deus se faz presente na vida e na história das pessoas. Essas analogias tratam sobretudo das nossas responsabilidades individuais e coletivas, colocando critérios para avaliar se estamos ou não fazendo a vontade de Deus, isto é, correspondendo ou não ao seu grande amor por cada um de nós.
A profecia de Isaías foi anunciada um pouco mais de um século antes do Exílio da Babilônia. O texto lido hoje pertence à “primeira fase” de Isaías. O profeta, então, denuncia os desmandos das autoridades, as situações de corrupção e de desrespeito à vida das pessoas. A linguagem utilizada é poética, que descreve uma vinha, um terreno cultivado por videiras. Assim como os resultados dos cuidados e do zelo pela plantação podem surpreender no sentido negativo na hora da colheita, assim as esperanças do amor muitas vezes não são correspondidas.
Na cultura judaica, a “vinha” é um símbolo do amor. Quando um relacionamento é sincero, honesto e dedicado espera-se que seja recíproco, fiel e duradouro. Neste caso, sendo a plantação o próprio povo de Israel escolhido por Deus, o que se esperava que eles fizessem? Quais deveriam ser suas atitudes? Será que Deus teria falhado? A Oração do Salmo ajuda entender melhor esse assunto.
que estão presentes nas comunidades cristãs? Por que Jesus se compara “a pedra que os construtores rejeitaram e que se tornou a pedra angular”?
Esta passagem representa bem a mensagem que o evangelista Mateus quer destacar no conjunto de todo seu Evangelho. Jesus vem cumprir as promessas do Antigo Testamento, Ele é o Messias esperado, o Enviado, porém seu anúncio traz novidades, Ele é o Messias diferente, seu Mandamento é o do amor e sua justiça não é legalista. Por isso, muitos não o acolheram, especialmente as autoridades.
Desta forma, entende-se melhor o que Jesus quis dizer na conclusão da parábola: “O Reino de Deus vos será tirado e entregue a um povo que produza fruto”. Os novos “agricultores arrendatários” seriam os pecadores convertidos e os gentios que aderem à fé em Jesus Cristo. Este “novo povo” e nós também estaremos sujeitos à mesma exigência que os antigos: produzir frutos de justiça, fazer com que se realize a vontade de Deus.
- Você consegue sentir os cuidados de Deus presentes na sua vida?
- Quando você percebe “frutos amargos” na sua vida e de sua comunidade?
- Como você poderá manter seus pensamentos e seu coração no caminho da santidade?
O profeta reconhece que Deus “cumpriu com a promessa”, realizou todos os cuidados com sua gente. Vemos que as uvas amargas são resultado dos desvios cometidos pelo povo em relação à Aliança feita com Deus, isto é, não praticando os Dez Mandamentos. As consequências dessas infidelidades levaram o povo a vivenciar invasões estrangeiras, causando sofrimento e tristeza.
A parábola do Evangelho sobre os “agricultores homicidas” faz uma releitura do cântico da vinha do profeta Isaías. Diante dos apelos de Deus, as situações da parte dos fiéis podem ser de fidelidade e responsabilidade ou às vezes não. Neste caso, se espera dos agricultores, dos cultivadores da vinha, “obras de bondade”, mas eles se apoderam da riqueza e não “prestam contas a Deus” pelos seus atos. O que está sempre em jogo são as responsabilidades e ações tanto pessoais como comunitárias da prática da justiça na realização concreta do Reino de Deus.
De que justiça se trata? Quais as atitudes que Jesus condena
Bem sabemos que a ausência de serenidade nos atrapalha muito e nos impede tantas vezes de sermos mais santos e felizes. Paulo escrevendo aos Filipenses faz um importante alerta: “Não vos inquieteis com coisa alguma”! É preciso ocupar os pensamentos e o coração com o que é verdadeiro, nobre, justo e amável, dentre outras coisas. Eis as condições para se viver a proposta de Jesus e ganhar o Reino de Deus.
O apóstolo se refere a uma mentalidade nova que se deve criar a partir da experiência com Cristo. São sábias orientações sobre um modo de ser que serviu de base para os primeiros cristãos buscarem a harmonia e a paz. Tal motivação deve ser também a nossa quando participamos em nossas comunidades, nas redes sociais e nos diferentes ambientes. Vamos divulgar mais os bons testemunhos e contribuir oferecendo soluções iluminadas pelo Espírito.

Dia 9: Jn 1,1-2,1.11; Jn 2,2.3.4.5.8; Lc 10,25-37
Dia 10: Jn 3,1-10; Sl 129(130); Lc 10,38-42
Dia 11: Jn 4,1-11; Sl 85(86); Lc 11,1-4
Dia 12 (Nossa Senhora Aparecida): Est 5,1b-2;7,2b-3; Sl 44(45); Ap 12,1.5.13a.15-16a; Jo 2,1-11
Dia 13: Jl 1,13-15;2,1-2; Sl 9A(9); Lc 11,15-26
Dia 14: Jl 4,12-21; Sl 96(97); Lc 11,27-28
Leituras: Is 25,6-10a; Sl 22(23),1-3a.3b-4.5-6; Fl 4,12-14.19-20; Mt 22,1-14
A imagem do “banquete” é presente ao longo de toda Liturgia, indicando amizade e partilha do próprio Cristo com o homem. Cristo oferece o seu Reino como um grande banquete gratuito, que deve ser, a todo momento, buscado e “agarrado” por todos. O convite é aberto, sem discriminação, privilégios, honrarias. Talvez, por ser tão simples, é que muitos o deixam em “último plano”, como algo sem importância alguma.
PRIMEIRA MESA: MESA DA FRATERNIDADE
Isaías aponta para um tempo de fraternidade e paz com a imagem deste grande banquete que há de acontecer sobre o Monte Sião, que é ponto de encontro do homem com Deus, pois ali se encontrava o Templo.
Banquete é sinal de amizade, fraternidade, partilha. É Deus que oferece este banquete de união entre todos, pois esta mesa posta sobre o Monte Sião, local de encontro, quer unir todos numa mesma mesa, festejando a fraternidade. Este banquete é único, descrito pelo profeta com comidas sofisticadas: manjares suculentos, vinhos deliciosos, comida de boa gordura. Ainda mais, como de costume, ao final de cada banquete, presentes eram ofertados, e neste banquete eles não faltam: o Senhor enxugará as lágrimas e aliviará o peso que está sobre o povo.
o convite são as lideranças do povo de Israel; os empregados que vão levar o convite são os profetas que, ao longo de muito tempo, anunciaram o messias justo juiz, pedindo conversão. Com estas imagens definidas, notamos a consequência: recusa do convite e morte dos empregados. Temos o grande ensinamento desta mesa da justiça: enquanto perdermos tempo em olhar nossos próprios interesses, instrumentalizando coisas e pessoas para objetivos particulares de poder e posses, a consequência imediata será a morte. Cristo quer propor um banque de justiça e fraternidade que contrasta com esta lógica de morte, propondo paz e união. Cristo insiste em chamar, não se contenta com uma recusa, insiste uma segunda vez. Contudo, a cegueira gerada pelo poder impede de ver o essencial.
TERCEIRA MESA: MESA DOS SIMPLES
- Quantas vezes já fui convidado ao banquete?
- O banquete da fraternidade, da justiça e da simplicidade é gratuito. Consigo cogitar uma mesa destas?
Eis o final da parábola: após a negação dos líderes, que são os primeiros a promover a justiça e a fraternidade, o convite então é feito a todos que estão pelo caminho. É uma mesa inclusiva, uma mesa de simplicidade, sem poderio e honrarias. É a mesa do povo do Deus. O banquete oferecido por Cristo é aceito na simplicidade do homem que vê em Deus Aquele que pode saciar.
SEGUNDA MESA: MESA DA JUSTIÇA
Jesus está em Jerusalém, centro de tudo: poderio político, econômico e religioso. Em meio a “poderes” usa de uma parábola: convite ao banquete. Mais uma vez a imagem do “banquete” é o centro, contrastando com as escolhas feitas pelos homens detentores do poder que nem sempre priorizam Deus, mas sim seus próprios interesses, instrumentalizando a política, a economia e a religião para benefícios escusos.
Este “banquete” de Jesus pode ser intitulado “banquete da justiça”, pois este tema vem acompanhando os últimos finais de semana e também o tema central em Mateus: a justiça do Reino.
Todo o relato do banquete é simbólico: o Rei é Deus, o filho é Jesus, o casamento recorda-nos a aliança de Deus com o homem e a participação neste banquete é comprometer-se com a justiça do Reino. Contudo, comprometimento implica conversão/mudança. No contexto apresentado, possivelmente, conversão/mudança não eram pautas negociáveis.
Continuando com as imagens, os convidados que recusam
Ainda há uma imagem importante: o traje de festa. Há alguém sem o traje. Historicamente não era necessário um traje “especial” para sentar-se à mesa. Pode-se compreender que este “traje de festa” seja a justiça, visto que é o tema que perpassa todo o Evangelho, segundo Mateus. Só pode sentar-se à mesa aquele que é justo.
Mas também, o “traje de festa” era a roupa do noivo e da noiva. Assim sendo, se estamos revestidos do traje da justiça, todos somos o “noivo” e a “noiva” no banquete de Cristo.

Dia 16: Rm 1,1-7; Sl 97(98); Lc 11,29-32
Dia 17 (Santo Inácio de Antioquia): Rm 1,16-25; Sl 18(19A); Lc 11,37-41
Dia 18 (São Lucas): 2Tm 4,10-17b; Sl 144(145); Lc 10,1-9
Dia 19: Rm 3,21-30; Sl 129(130); Lc 11,47-54
Dia 20: Rm 4,1-8; Sl 31(32); Lc 12,1-7
Dia 21: Rm 4,13.16-18; Sl 104(105); Lc 12,8-12
Leituras: Is 45,1.4-6; Sl 95(96),1.2a.3.4-5.7-8.9-10a.c; 1Ts 1,1-5b; Mt 22,15-21
A liturgia da Palavra nos apresenta um Deus infinitamente grandioso que nos ama e tem misericórdia de nós, trazendo-nos de volta para junto d’Ele quando desviamos do seu caminho.
A primeira leitura da profecia de Isaías nos apresenta a soberania de Deus na figura do rei persa Ciro. Deus se serve de pessoas para criar uma sociedade onde todos possam ter liberdade e vida. O profeta encontra-se exilado junto ao povo de Deus na Babilônia a fim de devolver-lhe a esperança no Deus da vida e da liberdade. O povo oprimido é o centro da atenção de Deus. Para exercer a justiça na história, Deus se serve de pessoas que até não pertencem ao povo escolhido.
dilha”? E pediu que levasse até Ele uma moeda, e eles levaram. Com outra pergunta Jesus disse: “De quem é a figura dessa moeda”? Eles responderam que era de César. Então disse Jesus: “Dai a César o que é de César e a Deus o que é de Deus”.
- Como ser imagem e semelhança de Deus em um mundo que tenta nos imprimir suas diversas imagens?
- O que é devolver a Deus o que é de Deus?
- Como ajudar a comunidade a se organizar?
O profeta fala do rei Ciro, um rei pagão, que embora não conhecesse, Deus o conhecia, tomou-o pela mão. Depois Ciro venceu a Babilônia, permitiu que os judeus voltassem à própria terra e começassem a reconstruir o Templo e a cidade. Ciro é chamado de “ungido”, como os reis de Israel, pois ele atua em favor de Israel. Ele se tornou um instrumento nas mãos de Deus para tornar conhecido o seu nome, de um Deus que salva.
Os herodianos e fariseus fizeram uma pergunta a Jesus para armar uma cilada, para pegá-lo em alguma palavra contrária a lei. Pensaram ter encontrado tal oportunidade na questão do imposto a pagar ao imperador romano César. Uma pessoa tão liberta como Jesus é uma ameaça para o poder, porque ela está disposta a dar a vida pela verdade.
Esse grupo heterogêneo apresenta-se diante de Jesus, primeiro elogiando sua fidelidade e sua liberdade com intuito de fazer uma armadilha. Perguntam a Jesus se é lícito pagar imposto a César. Se Jesus responder que é lícito estaria contrariando as expectativas sagradas de liberdade. Porém, se dissesse que não deveria ser pago, poderia ser preso por ir contra o imperador.
Jesus desmascara esse grupo chamando-os de “hipócritas”, e disse: “Por que me preparais uma arma-
Essa resposta de Jesus, além de lhes ensinar a coerência nas coisas políticas, lembra que eles estão esquecendo o mais importante: as exigências de Deus. Se não darmos a Deus o que é de Deus, nada podemos fazer de verdadeiramente valiosos. A sentença da resposta de Jesus é devolver a César o que lhe pertence e entregar-se a Deus sem reservas. Só Deus pode ser considerado o Senhor das pessoas e do mundo. A imagem do Deus da vida foi estampada em cada pessoa. O cristão não pode compactuar com o que põe em jogo a sua fé, pois tende a tirar sua liberdade e imprimir outra imagem substituindo a do seu criador.
Os Tessalonicenses são chamados de Igreja, significa uma comunidade organizada e unida. A Carta aos Tessalonicenses é o texto mais antigo do Segundo Testamento (NT), datado por volta do ano 51 d.C. Paulo, Silvano e Timóteo falam para essa comunidade com muito carinho e respeito. Reconhecem que os membros da comunidade de Tessalônica são escolhidos e amados por Deus. Admiram a fé desse povo, ou seja, a adesão a Jesus; os esforços para viver o amor, por em prática a fé; e louvam a constância na esperança. Afirmam que é o Espírito Santo que os conduz, dando força e confere a eficácia do Evangelho.

Dia 23: Rm 4,20-25; Lc 1,69-70.71-72.73-75; Lc 12,13-21
Dia 24: Rm 5,12.15b.17-19.20b-21; Sl 39(40); Lc 12,35-38
Dia 25 (Santo Antônio de Sant’Ana Galvão): Rm 6,12-18; Sl 123(124); Lc 12,39-48
Dia 26: Rm 6,19-23; Sl 1,1; Lc 12,49-53
Dia 27: Rm 7,18-25a; Sl 118(119); Lc 12,54-59
Dia 28 (Santos Simão e Judas, Apóstolos): Ef 2,19-22; Sl 18(19A); Lc 6,12-19
Leituras: Ex 22,20-26; Sl 17(18),2-3a.3bc-4.47.51ab; 1Ts 1,5c-10; Mt 22,34-40
Um pouco mais e concluiremos o Ano Litúrgico e o 3º Ano Vocacional, que tem por tema “Vocação, graça e missão”, com o lema “Corações ardentes e pés a caminho” (Lc 24,32-33). A Palavra de Deus nos acompanha a cada dia, nos orientando e colocando na direção que leva ao Pai. Como povo de Deus peregrino, para fazermos parte da Igreja de Cristo, basta abertura e despojamento pessoal, tendo nossos olhos voltados para Deus e amar nosso próximo como a nós mesmos.
Ser cristão implica na consciência de que nossa permanência nesse mundo é temporária, não somos daqui, pois, de Deus viemos e para Deus voltaremos. Somos um povo peregrino e a caminho. Não conseguimos explicar o porquê recebemos do Criador o dom da vida, e nem porque viemos na família que temos, no contexto em que estamos inseridos, nesse exato momento da história da humanidade.
Os relatos bíblicos nos apresentam que o pecado surgiu no mundo, a partir do momento em que o homem quis ser como Deus. De modo que tendemos a nos pôr no lugar de Deus, achando que tudo nos pertence e que não morreremos. Canalizando nossas energias para as realidades terrenas e nos fechando para a obra Divina. A ponto de não enxergarmos o próximo como nosso irmão, mas como um estranho e às vezes até como um adversário. Interessante conversar com nossos “nonos”, relembrando momentos desafiadores como o testemunho dos que vieram para o Brasil, fugindo de guerras e calamidades. Questão tão visível na colonização de nossa região. Lembramos com dor e ao mesmo tempo, com orgulho e honra, por tantos desafios e superações.
e semelhança de Deus.
É de nossa responsabilidade vivermos o amor fraternal, conforme São Paulo nos adverte, como seguidores de Cristo (cf. 1Ts 1,6), sem nos apegar as realidades terrenas, buscando de alma e coração cumprir a missão que Deus nos confiou. O que requer empenho e discernimento, dado que, no âmbito pessoal, afloram sonhos e impulsos diante dos quais não é tão simples ter clareza de quando é a vontade de Deus e quando é vontade própria. Há assim, a exigência de uma vida de oração, segundo a qual, busca-se mais do que as petições do orante, ouvir a voz de Deus.
No Evangelho, os fariseus que discordavam dos saduceus em alguns pontos, questionam a Jesus sobre qual é o maior dos mandamentos. Ao responder aos fariseus, Jesus manifesta que a plena revelação divina se manifesta no amor a Deus e aos irmãos, resumo de todos os demais Mandamentos, normas e proibições.
- Qual a história de vida de meus antepassados?
- Em meu viver, como tenho sido um imitador de Cristo?
- Como tenho observado os Mandamentos?
A Liturgia deste domingo nos leva a refletir também que imitar Cristo significa, em estado de completa obediência, colocar Deus em primeiro lugar, o que nos desafia por inteiro. Esvaziar-se a si mesmo, tomar sobre os próprios ombros as dores do próximo, é um modo de vida contrário à proposta de felicidade e realização que o mundo apresenta. Basta perceber que entre nós católicos, inclusive entre as lideranças, como estamos vivendo aos Mandamentos da Igreja: Ir nas missas aos domingos; confessar regularmente; comungar; jejuar; consagrar o Dízimo.
Por outro lado, ao olhar para a realidade presente de tantos irmãos, tantos países, com culturas e línguas diferentes, que estão à procura de condições de vida digna, em terras distantes, ao ouvir certos comentários, transparece uma amnésia, que afeta a memória dos fatos vividos pelos que aqui já estão há mais tempo e que também passaram por situações semelhantes.
É fato que para fazer parte do povo de Deus, não basta ser batizado. Muito mais do que receber o rito, pelo rito, a graça do Sacramento implica em assumir os compromissos inerentes ao modo de vida do ser cristão. Somos um povo a caminho, não para vivermos segundo as realidades da carne, movidos pelos impulsos do instinto de sobrevivência, pois, somos mais que os demais animais, uma vez que além da vida, recebemos também a alma, somos imagem
Compreende e vivencia esses Mandamentos a pessoa que colocando Deus em primeiro lugar, esvazia-se a si mesma, abrindo-se ao mistério da Salvação que se manifesta na comunidade a partir de práticas pessoais de purificação e santificação.
Leitura Diária

Dia 30: Rm 8,12-17; Sl 67(68); Lc 13,10-17
Dia 31: Rm 8,18-25; Sl 125(126); Lc 13,18-21
Dia 1º/11: Rm 8,26-30; Sl 12(13); Lc 13,22-30
Dia 2/11 (Finados): Jó 19,1.23-27a; Sl 23(24); 1Cor 15,2024a.25-28; Lc 12,35-40
Dia 3/11: Rm 9,1-5; Sl 147(147B); Lc 14,1-6
Dia 4/11 (São Carlos Borromeu): Rm 11,1-2a.11-12.25-29; Sl 93(94); Lc 14,1.7-11
Solenidade de Todos os Santos | 5 de novembro de 2023
Leituras: Ap 7,2-4.9-14; Sl 23(24),1-2.3-4ab.5-6; 1Jo 3,1-3; Mt 5,1-12a
Neste domingo celebramos a Solenidade de Todos os Santos. É a celebração da presença de Deus na vida de tantas pessoas, que se dedicaram ao amor a Deus e aos irmãos. Felizes e Bem-aventurados são todos aqueles que buscam viver os ensinamentos do Senhor. A liturgia deste final de semana nos ajuda a compreender o mistério da Salvação para todos os que buscam a santidade. A salvação vem de Deus, concedida a nós através de seu Filho que em tudo viveu as Bem-aventuranças, um caminho a ser vivido por nós para que sejam transformadas nossas dores, dificuldades e sofrimentos ao unirmo-nos à graça do Justo Sofredor.
O Sermão da Montanha ocupa três capítulos no Evangelho de Mateus, parte substancial do discurso de Jesus, pois neste momento o rosto do Filho se revela. Jesus é o Mestre que, através de sua Palavra, torna explícito o verdadeiro modo humano de se viver. Mediante o Cristo, torna visível o que São João diz na sua carta: “Vede que grande presente de amor o Pai nos deu: de sermos chamados filhos de Deus!” (1Jo 3,1a). Neste sentido, Cristo sendo nosso irmão, revela nas Bem-aventuranças uma regra de vida para todos os batizados, pois “o mistério do homem só se torna claro verdadeiramente no mistério do Verbo encarnado” (GS 22).
bres em espírito e dos perseguidos, pois é preciso ser capaz de acolher com alegria o dom concedido por Deus. Sendo pobre, vivo apenas do que Deus me concede como graça e ainda assim sou perseguido por viver contracorrente do que o mundo oferece. Na certeza de receber os dons de Deus caminho para um mundo futuro diferente, enfrentando as realidades com espírito corajoso e alegre. Bem-aventurados são os pobres em espírito, os mansos, os aflitos, os que tem fome e sede de justiça, os misericordiosos, os puros de coração, os promotores da paz, os injuriados e perseguidos.
- Quais ensinamentos tenho seguido em minha vida de fé?
- Estou aberto à experiência de ser bem-aventurado?
- Tenho vivido atitudes humanas capazes de vencer as injustiças causadas pelos desamores?
A verdadeira identidade dos bem-aventurados é viver felizes em condição de graça, progredindo na graça de Deus e no caminho de Deus ao buscar continuamente a conversão e a santidade. A realidade que o próprio Cristo vive revela a condição que muitos se encontram em nosso mundo. Se formos capazes de perceber que Deus vai nos concedendo sua Graça a cada dia, receberemos as condições para superar nossas realidades desafiadoras e dolorosas para nos tornarmos mais humanos na busca pela Salvação. Assim como Cristo passou por aflições e perseguições sendo pobre no espírito, manso, misericordioso e puro de coração nós somos convidados a trilhar este caminho da verdadeira Identidade cristã de seres humanos.
No Evangelho são descritas nove bem-aventuranças que revelam o modo como Deus compreende a verdadeira face humana. Jesus nos ensina continuamente e repete insistentemente as palavras “bem-aventurados”, para que penetre em nosso coração a verdadeira justiça de Deus, que se realiza mediante o Amor. A raiz da felicidade se encontra, em nosso mundo, corrompida pelos vícios e prazeres desenfreados, condições que não nos trazem a verdadeira felicidade, mas nos afunda em uma vida de princípios consumistas e egoístas. Diante disso, Jesus propõe um novo modo de viver de acordo com a verdadeira alegria, aquela que exalta ao receber um presente, um dom, uma graça que necessita.
A primeira e a oitava bem-aventurança estão no presente, já se realizam hoje em nossa história. O Reino do Céus é dos po-
Colocar-se no caminho do seguimento de Jesus é um desafio ao qual somos chamados para sermos santos. Exige de nós a pobreza, a capacidade de ser humildes e nos colocarmos diante de Deus como necessitados da sua graça para amarmos mais. Nossa aflição nos faz transbordar nosso sofrimento interior diante de Deus. Assim, só nos cabe sermos mansos por experimentar tão grande amor de Deus. Sendo limitados não fazemos valer nossos direitos e egoísmos, mas iluminados pelo Espírito Santo temos fome e sede de justiça para perceber as necessidades dos nossos irmãos. Isso nos ensina a ser mais sensíveis e misericordiosos tendo compaixão ao ver a dor daqueles que mais sofrem e dos mais pobres.
Neste caminho de configuração com Cristo resta-nos ter um coração puro, capaz de um olhar transparente para a realidade e nela descobrir os sinais e a presença de Deus. Sendo capazes de levar dentro de si Deus, que é infinito, somente desta forma transbordaremos em nossas atitudes e ações a paz, que promove a fraternidade entre os irmãos. Tenhamos, pois, a consciência de que nosso esforço pelo Amor e para o Amor, que é Deus, custou a cruz para o Cristo, o grande pacificador. Portanto, todos nós, enquanto Igreja, somos convidados a nos convertermos para este verdadeiro caminho de santidade que nos eleva a Deus. Sejamos corajosos para que, com a força do Espírito Santo, enfrentemos as injustiças e saibamos viver nossa fé no amor ao Pai, que é Deus e aos nossos irmãos.

Dia 6/11: Rm 11,29-36; Sl 68(69); Lc 14,12-14
Dia 7/11: Rm 12,5-16a; Sl 130(131); Lc 14,15-24
Dia 8/11: Rm 13,8-10; Sl 111(112); Lc 14,25-33
Dia 9/11 (Dedicação da Basílica do Latrão): Ez 47,1-2.8-9.12; Sl 45(46); Jo 2,13-22;
Dia 10/11 (São Leão Magno): Rm 15,14-21; Sl 97(98); Lc 16,1-8
Dia 11/11: Rm 16,3-9.16.22-27; Sl 144(145); Lc 16,9-15
No artigo anterior iniciamos nosso estudo sobre os Ritos Iniciais da missa que têm como finalidade “fazer com que os fiéis reunidos constituam uma comunidade celebrante, disponham-se a ouvir atentamente a Palavra de Deus e a celebrar dignamente a Eucaristia” (Instrução Geral do Missal Romano, nº 46). Tratamos também da procissão de entrada acompanhada pelo canto.
Continuando nosso estudo vamos aqui tratar de mais outros dois ritos que fazem parte da abertura da celebração: o beijo do altar e sua incensação. Estes ritos colocam em evidência a importância que ocupa o altar na celebração da Eucaristia: a procissão de entrada se encaminha para ele; a cruz e os castiçais, trazidos em procissão, são colocados junto dele; o Evangeliário, também trazido em procissão, é colocado sobre ele (cf. IGMR, nº 122,188). O altar é beijado e incensado (cf. IGMR, nº 123). Vamos aqui entender o sentido desses ritos que fazem parte dos ritos iniciais da celebração da missa.
Quanto a este gesto, a Instrução Geral do Missal Romano nos diz que “chegando ao presbitério, o sacerdote, o diácono e os ministros saúdam o altar com uma inclinação profunda. Em seguida, em sinal de veneração, o sacerdote e o diácono beijam o altar” (nº 49). Vemos aqui, por esta indicação que, na celebração eucarística o beijo do altar é dado pelos ministros ordenados presentes (diáconos, padres, bispo), em sinal de veneração, símbolo de Cristo.
Este gesto no início da celebração remonta a tempos muito antigos em que, além do beijo do altar, beijava-se também o livro dos Evangelhos ou Evangeliário, como também o beijo trocado entre os ministros da celebração, conforme nos atesta o famoso Ordo Romanus 1, que descreve como se realizavam as cerimônias da missa presidida pelo Papa na cidade de Roma. Segundo esse documento, no
início da celebração, os ministros beijavam o Evangeliário e o altar porque respectivamente representavam Cristo nos dois ritos centrais da missa, ou seja, a Liturgia da Palavra e a Liturgia Eucarística. Já o beijo que os ministros trocavam entre si seria uma manifestação da mútua afeição e do amor fraterno que deveria transbordar em toda comunidade cristã.

Na antiga missa solene do Papa, quando este chegava ao altar, três cardeais da ordem dos padres lhe saudavam, oferecendo-lhe o beijo e, após a incensação do altar, três cardeais da ordem dos diáconos também saudavam o Papa, oferecendo-lhe o beijo da paz. Tais costumes, porém, cessaram durante o período da Idade Média. Já o beijo do Evangeliário no início da missa continuou por muito tempo. Chegando ao altar, o bispo beijava o texto do Evangelho do dia e, estando o Evangeliário sobre o altar, o mesmo era também beijado por outros celebrantes. A partir do século X, durante o beijo do Evangeliário, o bispo pronunciava, sempre em latim, as seguintes palavras: “A paz de Cristo que vem a nós por meio do seu Evangelho, confirme e conserve nossos corações e nossos corpos para a vida eterna”. A partir do século XII começou-se a beijar também o crucifixo do altar. Mas tal beijo foi pas-
sando cada vez mais do crucifixo material ao desenho do crucifixo impresso sobre as folhas do Missal.
De todas as saudações realizadas no início da missa, permaneceu em vigor na Liturgia apenas o beijo do altar. Na renovação litúrgica do Concílio Vaticano II, o beijo da mesa da Eucaristia na missa volta a ser considerado simplesmente como sinal de veneração e se limita ao beijo dado no início pelo presidente da celebração e pelos presbíteros e diáconos concelebrantes. No final da missa, somente o celebrante principal e os diáconos beijam o altar outra vez (IGMR, nº 90). O Cerimonial dos Bispos fala explicitamente do beijo do altar dado pelo bispo também nas vésperas solenes; portanto, não se refere somente à celebração eucarística.
O beijo é um gesto simbólico presente em quase todas as culturas e religiões. As pessoas beijam-se para demonstrar afeto, amizade e amor; para dar boas-vindas ou despedidas; para exprimir alegria ou felicitação. Também se beijam objetos que apreciamos ou que tenham algum significado importante.
Na Bíblia, este gesto encontra-se em
contextos muito variados. O Cântico dos Cânticos começa o seu poema de amor desta forma: “Que ele me beije com beijos da sua boca” (1,2). A mulher pecadora beija os pés de Jesus para lhe mostrar o seu respeito e amor. Paulo dirá aos cristãos de Roma: “Saudai-vos uns aos outros com um beijo santo” (Rm 16,16). Precisamente, pelo sentido positivo deste gesto, se interpreta como traição o beijo de Judas porque deveria significar uma coisa e realizou outra.
O beijo do altar sempre representou e, ainda hoje, representa nossa reverência a Cristo, pedra angular, rocha espiritual, único templo, sacerdote e vítima da nova aliança. Assim, o beijo dado à mesa começou a ser entendido como um beijo a Cristo.

O centro de nossa fé cristã é o sacrifício de Cristo, sua total entrega por nós confirmada pela Ressurreição e o dom do Espírito. Ora, esta entrega se faz hoje presente precisamente sobre o altar de nossas igrejas, toda vez que celebramos o memorial da Páscoa, na Santa Missa. E mais, como explicita a Instrução Geral do Missal Romano: o altar “é também a mesa do Senhor na qual o povo de Deus é convidado a participar por meio da Missa; é ainda o centro da ação de graças que se realiza pela Eucaristia” (nº 296).
Em se tratando do altar vale ressaltar que “sobre a mesa do altar podem ser colocadas somente aquelas coisas que se requerem para a celebração da Missa, ou seja, o Evangeliário, do início da celebração até a proclamação do Evangelho; desde a apresentação das oferendas até a purificação dos vasos sagrados, o cálice com a patena, o cibório, se necessário, e, finalmente o corporal, o sanguinho, a pala e o Missal” (IGMR, 306).
Tamanha é a importância da mesa do altar que, na celebração do Matrimônio, “terminada a celebração, as testemunhas e o ministro assinam a ata de casamento na sacristia ou diante do povo, mas nunca sobre o altar (Ritual do Matrimônio, nº 117).
Quanto a toalha que se coloca sobre o altar não deve escondê-lo: “Em reverência para com a celebração do memorial do Senhor e o banquete em que se comungam o seu Corpo e Sangue, ponha-se sobre o altar onde celebra ao menos uma toalha de cor branca, que combine, por seu formato, tamanho e decoração, com a forma do mesmo altar” (IGMR, nº 304).
O altar, assim sendo, é o ponto de convergência e atenção dentro do espaço celebrativo, pois ele nos traz presente à memória o que é mais sagrado para nós: Cristo em sua entrega total por nós, ontem, hoje e sempre.
“O beijo do altar sempre representou e, ainda hoje, representa nossa reverência a Cristo, pedra angular, rocha espiritual, único templo, sacerdote e vítima da nova aliança. Assim, o beijo dado à mesa começou a ser entendido como um beijo a Cristo. O centro de nossa fé cristã é o sacrifício de Cristo, sua total entrega por nós confirmada pela Ressurreição e o dom do Espírito”.
era clássico o rito do incenso (cf. Êx 30). A rainha de Sabá trouxe para Salomão, entre outros presentes, grande quantidade de aromas (cf. 1Rs 10). Os Magos do Oriente ofereceram incenso, além de mirra e ouro, ao Menino de Belém, como Isaías tinha anunciado (Is 60,6).
Só no século IV os cristãos introduziram a linguagem simbólica do incenso nas suas celebrações, quando se considerou superado o perigo anterior de confusão com os ritos idolátricos do culto romano.
No início da celebração, após o beijo do altar, o sacerdote “incensa a cruz e o altar, contornando-o” (IGMR, nº 123, 276). Aproveitando tal oportunidade vamos refletir sobre o sentido que tem a incensação na celebração da missa.
Incenso é uma resina que, ao arder, produz um agradável aroma. A palavra vem do latim incendere (acender), dá origem também ao termo “incensário”, instrumento metálico para incensar. Já a palavra turíbulo, vem da raiz grega thus, que também significa incenso, de onde vem as palavras turíbulo, vaso suspenso por pequenas correntes, usado nas igrejas para nele queimar-se o incenso e turiferário, que é aquele que o transporta.
A Instrução Geral do Missal Romano nos diz que “o incenso pode ser usado facultativamente em qualquer forma de missa: durante a procissão de entrada; no início da missa, para incensar a cruz e o altar; à procissão e à proclamação do Evangelho; depostos o pão e o cálice sobre o altar, para incensar as oferendas, a cruz e o altar, bem como o sacerdote e o povo; à apresentação da hóstia e do cálice, após a consagração.
Usa-se o incenso sobretudo no Oriente e, desde muito antigamente no Egito, antes de chegarem os israelitas. Usava-se o incenso nas cerimônias religiosas, pelo seu fácil simbolismo de perfume e festa, de sinal de honra e respeito ou de sacrifício aos deuses. Ao redor da Arca da Aliança e, sobretudo, no Templo de Jerusalém,
Atualmente, quando se quer ressaltar a festividade do dia, na missa, ao ofertório, incensa-se o altar, as imagens da cruz ou da Virgem, o livro do Evangelho, as oferendas sobre o altar, os ministros e o povo cristão e, depois da consagração ou nas celebrações de culto eucarístico, incensa-se também o Santíssimo. Com isso se quer significar um gesto de honra (ao Santíssimo, ao corpo do defunto nas exéquias), ou um símbolo de oferenda sacrificial (no ofertório, tanto o pão e o vinho como as pessoas).
Incensam-se os sinos, quando se benzem; o Círio Pascal, antes de cantar o Precônio; as paredes da igreja, na sua Dedicação; os sepulcros. Nas exéquias, incensar os restos mortais do defunto exprime o apreço que a comunidade cristã sente por esse corpo que foi templo do Espírito e está destinado a ressurreição e, ao mesmo tempo, expressa o sentido de oferenda total e definitiva que a morte supõe.
A oração é algo interior, que se manifesta exteriormente com a voz, o canto, as posturas corporais, e também com a fumaça suave e o perfume do incenso. O Salmo 141(140),2 diz: “Suba até vós a minha oração como incenso”, e o Apocalipse diz que “as taças de ouro cheias de perfumes, que são as orações dos Santos” (5,8), e “veio um anjo, com um turíbulo de ouro na mão, e colocou-se de pé junto do altar. Foram-lhe dadas muitas espécies de aromas, para que os oferecesse com as orações de todos os Santos, sobre o altar de ouro que está diante do trono. E das mãos do anjo subiu à presença de Deus a fumaça dos aromas com as orações dos Santos” (8,3-4).
Na sequência dos ritos iniciais da missa vem o sinal-da-cruz; a saudação daquele que preside; o ato penitencial; o hino de louvor e a oração inicial ou “coleta”. Mas estes são assuntos para os próximos artigos.
Pe. Sérgio Augusto Rodrigues Assessor diocesano da Pastoral Litúrgica
Imagens ilustrativas


Um clube de benefícios para você!
Compre produtos e garanta



A cada R$ compras você ganha 1 número da sorte
concorre a




Campanha válida de 01/08/2023 a 19/12/2023.
Sorteios serão realizados pela loteria federal. Confira regulamento no site da campanha.

Concorra a R$ 14.000,00 em vale-compras com números da sorte virtuais.
Acesse: clubemaiscopagril.com.br faça seu cadastro e boa sorte!!
Nunca a vida humana foi tão ameaçada pelas pessoas que mantêm o poder dos meios de comunicação e das redes sociais. As informações estão sendo colocadas de forma tão permissiva que já não se sabe o que de fato é verdade ou não, e com isso estamos sendo iludidos e entrando no jogo de interesse daqueles que se beneficiam com o caos gerado. Estão conseguindo mudar a mentalidade da sociedade colocando como um processo evolutivo da humanidade esse caos para o qual estamos caminhando.
Devemos ter atenção a algumas movimentações no âmbito político e na sociedade que buscam de todas as formas implantar e aprovar projetos que vão contra os ensinamentos cristãos, como aborto, eutanásia, suicídio assistido, dentre outros.
Estamos perdendo a noção do que é bom ou mau, cansamos de escutar diariamente através dos meios de comunicação e até mesmo pessoas que nos cercam falando “o corpo é meu, faço dele o que quiser”, sem respeitar o que Deus nos ensina no Evangelho: nosso corpo é morada de Deus.
Nunca antes a cultura de que “tudo pode” esteve tão na moda principalmente entre os jovens. Pessoas sendo excluídas a todo momento, vidas de muitos inocentes sendo interrompidas de forma trágica e uma juventude cada vez mais perdida e sem rumo.
Nós, como cristãos, temos o compromisso de lutar para que essa indiferença que gera tanto mal não prevaleça, tendo o bom senso de buscar ações e iniciativas que consigam mostrar o verdadeiro sentido e o valor que a vida humana tem.
A Comissão Episcopal Pastoral para a Vida e a Família da CNBB nos convida neste ano a refletirmos sobre a adoção durante a Semana Nacional da Vida, de 1º a 7 de outubro. Quando ainda presidia esta Comissão, D. Ricardo Hoepers – atual secretário geral da CNBB – destacou
o objetivo da proposta: “Queremos promover, defender e cuidar para que o tema da adoção seja cada vez mais valorizado e salvaguardado como um grande tesouro espiritual para aqueles que desejam abrir suas famílias a tantas crianças e jovens que aguardam um lar. Queremos fazer ecoar no Brasil este lindo tesouro que é a adoção, isto é, um amor partilhado entre nós, que ultrapassa os laços sanguíneos e nos torna participantes de um amor ainda maior, onde todos nos sentimos filhos e filhas de Deus”.
No Catecismo da Igreja Católica, vemos que “A vida humana é sagrada porque, desde a sua origem, postula a ação criadora de Deus e mantém-se para sempre numa relação especial com o
“Queremos ecoar no Brasil este lindo tesouro que é a “adoção”, isto é, um amor partilhado entre nós, que ultrapassa os laços sanguíneos e nos torna participantes de um amor ainda maior, em que todos nos sentimos filhos e filhas de Deus”. (D. Ricardo Hoepers, ex-presidente da Comissão Episcopal Pastoral para a Vida e a Família da CNBB)

Criador, seu único fim. Só Deus é senhor da vida, desde o seu começo até ao seu termo: ninguém, em circunstância alguma, pode reivindicar o direito de dar a morte diretamente a um ser humano inocente” (CIC, nº 2258).
Portanto fortalecer a família é fundamental. Pais e mães devem assumir o compromisso de educar os filhos baseado nos valores e na fé cristã, mostrando a importância e a necessidade de promover, defender e cuidar da vida em todas as suas etapas.

Euclides José Angeli e Shirlei Aparecida

Mative Angeli
Casal coordenador diocesano do Setor Vida e Família
Semana Nacional da Vida quer ecoar a abertura dos casais para a adoção


Meu objetivo com esse texto é, primeiramente, esclarecer dois conceitos frequentemente mal compreendidos: ganância e ambição. Além disso, pretendo demonstrar que o planejamento financeiro vai além de simplesmente reduzir gastos para ter dinheiro extra no final do mês. Ele pode te ajudar na realização dos seus sonhos pessoais, como uma viagem em família. Ao final, vou utilizar meu exemplo de como consegui viajar para o exterior me planejando financeiramente.
Após essas considerações iniciais, vamos aos conceitos: a palavra “ganância” carrega consigo o sentido de um desejo humano exacerbado por dinheiro, bens e outras riquezas. Por outro lado, a “ambição” pode ser compreendida como o desejo humano de alcançar algo significativo que demande trabalho duro, determinação e perseverança.
Notou a diferença? Embora sutil, é exatamente nela que reside uma das principais mensagens que almejo transmitir com este texto. A ganância coloca o dinheiro como o objetivo final, ou seja, a meta é acumular mais e mais riqueza, sem um propósito definido. Em contrapartida, a ambição não gira em torno do acúmulo de dinheiro, bens e riquezas, seu propósito é, de fato, aumentar os ganhos financeiros, mas o dinheiro em si não é a meta final, ao invés disso, a ambição busca uma melhoria na qualidade de vida, o cuidado com a família, proporcionar conforto aos filhos, viagens e outras realizações, repare como o foco muda de uma situação para outra.
Neste momento, você provavelmente está se questionando por que estou discorrendo sobre a distinção entre ambição e ganância em um texto sobre planejamento financeiro. A razão é que muitos indivíduos têm receios ou acreditam que buscar mais dinheiro é errado, mas, na verdade, quando empregado de maneira adequada, o dinheiro pode proporcionar uma série de benefícios tanto para sua própria vida quanto para a vida das pessoas que
estão ao seu redor.
Portanto, proponho a você que a partir de hoje seja uma pessoa ambiciosa e trabalhe duro diariamente para melhorar a sua condição financeira. Contudo, é crucial que evite cair na armadilha de se tornar submisso ao dinheiro, mantenha o controle sobre ele e utilize-o de maneira inteligente, sempre visando o melhor proveito.
Encerrada a discussão sobre ganância e ambição, iniciamos a parte mais importante deste texto, como realizar sonhos através do planejamento financeiro.
O primeiro aspecto consiste em definir o que é o planejamento financeiro. De forma resumida, o planejamento financeiro é uma ferramenta que tem como objetivo te ajudar a administrar suas finanças pessoais, mas não se assuste, não é necessário ter aquelas planilhas super elaboradoras, basta ter uma compreensão clara da sua renda e despesas, ter a capacidade de avaliar se seus gastos estão alinhados com sua realidade, metas e sonhos.
Caso tenha interesse em aprender como desenvolver um planejamento financeiro do zero, há excelentes conteúdos on-line, especialmente no YouTube. Só fique atento às promessas exageradas de alguns “coaches” financeiros. Nesse sentido, como o planejamento financeiro te ajudará a ter uma clareza sobre os seus gastos e renda, se o seu sonho for realizar uma viagem, você irá ajustá-lo para que uma parte da sua renda seja destinada a isso. O processo parece simples, e de fato é. Naturalmente, será necessária a eliminação de certos gastos supérfluos, como compras de roupas desnecessárias ou pedidos de comida por delivery todo fim de semana. Contudo, é importante lembrar que sacrifícios fazem parte desse percurso e quando você finalmente alcançar sua meta financeira, cada esforço terá valido a pena.
Agora, como prometido vou comentar sobre a minha viagem mais recente, para Cusco, no Peru. Programamo-nos com dez meses de antecedência, de-
cidimos as datas e, em seguida, mergulhamos no estudo do custo dessa empreitada. Como prefiro viajar por conta, sem auxílio de agência de turismo, o primeiro passo foi verificar o valor das passagens aéreas. Como este é o maior gasto costumo optar por parcelar o pagamento no cartão de crédito, aproveitando o maior número possível de parcelas sem juros, isso me permite evitar um desembolso significativo de uma vez e, ao mesmo tempo, manter o dinheiro investido enquanto vou quitando as parcelas.

Com relação a hospedagem, minha prioridade foi encontrar a localização mais vantajosa para evitar gastos extras com deslocamentos de táxi ou aplicativos. Quanto à alimentação diária nesse destino, fiz uma estimativa média de gastos em torno de R$ 100,00, é importante ressaltar que esse valor pode variar consideravelmente conforme o local visitado.
Após pesquisar e conhecer bem o nosso destino, já havia calculado os custos dos passeios que tínhamos planejado realizar, a partir disso, direciona-
“Como o planejamento financeiro te ajudará a ter uma clareza sobre os seus gastos e renda, se o seu sonho for realizar uma viagem, você irá ajustá-lo para que uma parte da sua renda seja destinada a isso. O processo parece simples, e de fato é. Naturalmente, será necessária a eliminação de certos gastos supérfluos (...). Contudo, é importante lembrar que sacrifícios fazem parte desse percurso e quando você finalmente alcançar sua meta financeira, cada esforço terá valido a pena”.
mos uma parcela mensal da nossa renda para essa viagem ao longo dos meses que a antecederam. Esse planejamento nos permitiu desfrutar da estadia sem preocupações financeiras quando o dia finalmente chegou.
Por fim, gostaria de compartilhar algumas dicas valiosas para a sua próxima viagem.
Recomendo sempre abrir o navega-


dor em modo de navegação anônima ao verificar os preços das passagens, isso porque as companhias aéreas rastreiam o endereço IP do seu dispositivo eletrônico e podem aumentar os preços com base na quantidade de pesquisas realizadas.
Na hora de reservar um hotel, uma boa estratégia é usar plataformas que compara preços em diversos sites e aplicativos de reserva. Além disso, verifique os valores dos hotéis em diferentes dispositivos, como celulares e computadores, pois há relatos nas redes sociais de que os preços podem variar dependendo da marca do aparelho.
Com essas dicas, você poderá economizar um bom dinheiro, que poderá ser utilizado para desfrutar de uma refeição em um excelente restaurante durante sua estadia no destino.
Agradeço por dedicar seu tempo a esta leitura e espero te encontrar em algum destino turístico pelo mundo. Até logo.
Gabriel Felipe Knapp AdvogadoNo dia 9 de setembro de 2023, foram comemorados em Aparecida (SP) os 50 anos de Pastoral da Juventude no Brasil, e há 45 anos essa Pastoral está presente na nossa Diocese de Toledo com muita força e caminhada, atuando na sociedade e na comunidade, onde os próprios jovens são protagonistas de sua evangelização, assumindo-se evangelizadores de outros jovens. Nessa energia jubilar, vamos caminhar no nosso solo sagrado e conhecer um pouco da história da PJ na Diocese de Toledo.
A Pastoral da Juventude teve início na nossa Diocese em 15 de abril de 1978 quando reuniram-se jovens de grupos de base de todas as paróquias para a escolha do primeiro coordenador diocesano da PJ, Vitor Hugo Maciel, da cidade de Palotina. Para compor a coordenação diocesana, juntamente com ele, estavam Pe. Valdir Bisognin (em memória), Argentino Marçal Veloso, Ladi Konrat, Darci Konrat, Idenir Savegnhago e Beatriz Tebaldi. A partir daquela data iniciava a organização da PJ na nossa Diocese. Neste mesmo ano, a coordenação diocesana da PJ propõe sua organização diocesana em quatro setores, o que chamamos de Decanatos e, assim desde então, passou-se a ter esta preocupação de organizar a juventude a partir de quatro decanatos: Assis, Palotina, Rondon e Toledo.



Em mais um momento histórico, no dia 5 de agosto de 1984, aconteceu uma “Concentração Diocesana” no Ginásio de Esportes Alcides Pan, em Toledo. “Segundo o Jornal Oeste, da cidade de Toledo, estavam reunidos mais de 6 mil jovens”. Pelo que consta, neste período o coordenador diocesano era Arciso Wolf e o assessor era o então Pe. Anuar Battisti.
Pelo que consta, houve um período de desarticulação entre os anos 1985 e 1986. Até maio de 1985 houve uma coordenação provisória encabeçada por Nésio. Com a saída desta coordenação provisória nenhum setor (Decanato) quis assumir a coordenação, o que era uma prática até então. Desta forma, “decidiu-se formar uma comissão com representantes dos quatro setores para expor a situação ao bispo. Esta comissão assumiu por tempo indeterminado. A consequência dessa situação foi que os setores praticamente inexistiram de forma articulada nos anos de 85 e 86. Apenas no setor de Assis, segundo o Pe. Lino, assessor do Setor Palotina, havia algum trabalho.
No período de 1986 a 1992 a Pastoral da Juventude ganhou um novo impulso a partir do incentivo do então bispo D. Lúcio Ignácio Baumgaertner, que trouxe para a Diocese as propostas do Documento 44 que tinha como título “Pastoral da Juventude no Brasil”. A partir daquele ano, o ainda seminarista Hélio José Bamberg
– atualmente pároco da Catedral Cristo Rei – assumiu a assessoria diocesana e permaneceu até o ano de 1992. Neste período acontecem as formações de lideranças jovens, tanto em nível de decanatos como também em nível diocesano. Estas formações variavam de três a cinco etapas. Usava-se o método “Ver, Julgar e Agir”, e os temas trabalhados eram: psicoafetividade; análise de conjuntura, cristologia, eclesiologia e outros.
No dia 25 de outubro de 1992 acontece o 1º Congresso Diocesano da Juventude no Ginásio de Esportes Alcides Pan, em Toledo, reunindo cerca de 8 mil jovens. O tema celebrado foi “Juventude: conhecendo e fazendo história”.
A partir de 1993 quem assume a assessoria diocesana é o Pe. Sérgio Augusto Rodrigues. A PJ continua articulada em nível diocesano, com coordenações nos quatros decanatos, realizando encontros diocesanos e formações de lideranças.
No dia 21 de setembro de 1997, novamente no Ginásio de Esportes Alcides Pan acontece o 2º Congresso da Juventude, agora com característica ecumênica, mas encabeçado pela Pastoral da Juventude. Este Congresso Ecumênico da Juventude tinha como tema “Oikoumene”. Também reuniu milhares de jovens de toda a Diocese.
Podemos dizer que as décadas de 1980 e 1990 foram marcadas por um grande número de grupos de base. Algumas paróquias chegavam a ter mais de 20 grupos de jovens, pois era comum cada comunidade ter o seu próprio grupo. Este período também foi marcado pela realização de torneios esportivos e festivais de música. Na preparação do Congresso de 1992, por exemplo, cada Decanato realizou o seu festival de música sacra, e os classificados de cada decanato disputaram a grande final no dia do congresso.
Pe. Sérgio permaneceu como assessor eclesiástico diocesano até o ano 2003. A partir daquele ano assumiu a assessoria eclesiástica o Pe. Roberto Lopes de Souza. Nesta época o coordenador diocesano era o Paulo Cezar Weber.
Entre os anos de 2003 e 2004 foi realizada uma Missão Jovem, proposta a partir de
“A Pastoral da Juventude está presente na nossa Diocese de Toledo com muita força e caminhada, atuando na sociedade e na comunidade, onde os próprios jovens são protagonistas de sua evangelização, assumindo-se evangelizadores de outros jovens. Nessa energia jubilar, vamos caminhar no nosso solo sagrado e conhecer um pouco da história da PJ na Diocese de Toledo”.
sugestões dadas em encontros e reuniões diocesanas e decanais. Esta missão era realizada nas paróquias, com o objetivo de animar os grupos que já existiam e formar novos grupos.

Quanto à celebração do Dia Nacional da Juventude (DNJ), até o ano de 2003 este evento era realizado pela PJ em nível de decanatos. A partir de 2004 tornou-se um evento diocesano. Assim continuou até o ano de 2007, sendo que nos anos de 2004 e 2005 ele foi realizado em Nova Aurora. No ano de 2006, em Toledo, e no ano de 2007 em Assis Chateaubriand.
No final de 2007 foi criado na Diocese o Setor Juventude com o objetivo de promover uma maior integração e comunhão entre as diversas expressões juvenis. Com
isso, a partir de 2008 o DNJ deixou de ser um evento organizado somente pela Pastoral da Juventude e passou a ser organizado pelo Setor Juventude Diocesano.
No ano de 2005 foi criado o site www. pjtoledo.org.br. Este site durou uns três ou quatro anos, contendo informações importantes sobre a Pastoral da Juventude, principalmente fotos de eventos. Porém, em pouco tempo ele deixou de ser atualizado, pois faltavam pessoas que se dedicassem a esta função. Além disso, tinha um pequeno custo mensal, pois era preciso pagar o registro do site, sem contar que, com a evolução das redes sociais, os sites foram se tornando menos utilizados.
No ano de 2006 a Pastoral da Juventude criou um jornal intitulado “PJ em Ação”, com uma tiragem inicial de 500 unidades. Eram oito páginas contendo informações e sugestões de encontros para os grupos de base. Já no final de 2006 a tiragem foi
Nesse contexto de resgate da história da PJ na Diocese de Toledo, recordamos os coordenadores diocesanos que tivemos até aqui e que contribuíram com essa linda caminhada.
1978 a 1980 – Vitor Hugo Maciel (Palotina)
1981 a 1982 – Eloi Urnau
1983 a 1984 – Arciso Wolf (Toledo)
Até maio de 1985 – Coordenação provisória: Nésio, Rosinha, Irineu, Eugênio, Lisete.
1985 a 1986 – Comissão provisória
1987 – Valdir Cordeiro (Toledo)
1988 – Vera Lucia da Silva (Guaíra)
1989 a 1995 – Neudi Mosconi (Toledo)
1996 a 1998 – Rosângela Maria Pontili (Toledo)
1998 a 2000 – Cloves Luis Angeleli (Assis Chateaubriand)
2001 a 2003 – Paulo Cezar Weber (Toledo)
2004 a 2005 – Rodrigo Furlan Marchezoni (Jesuítas)
2006 a 2007 – Fabian José Giordani (Toledo)
2008 – Éderson dos Santos Izeli (alguns meses, Assis Chateaubriand)
2008 a 2010 – Juciani Mudolon (Nova Aurora)
2011 – Juliana Graciele Reinke (Toledo)
2012 a 2013 – Bruna Zorzo (Toledo)
2014 a 2016 – Giovani Bessegato (Toledo)
2017 a 2018 – Jennifer Teixeira (Toledo)
2019 - Alex Sander (Toledo)
2020 a 2021 – Thaís Cristina Coelho (Toledo)

2022 – Eliane Leal da Silva (Toledo)
2023 – Flávia Barbosa (Nova Aurora)
aumentada para 1.200 unidades. No ano de 2010 este jornal mudou o nome para “Jovens em Ação”, visando com isto ser mais inclusivo em relação às outras expressões juvenis da Diocese. Assim ele permaneceu até 2011. Sua última publicação foi a de julho a setembro de 2011. Parou de ser publicado porque se percebeu que estava sendo pouco utilizado pelos grupos de base. Intensificava-se cada vez mais o uso da internet e das redes sociais.
É importante destacar que há muito tempo a PJ na Diocese de Toledo valoriza a formação e a organização de assessores. Porém, já tivemos muitas dificuldades para ter uma equipe sólida que cultivasse esta identidade de assessores. Pensando nisso, foi criada a 1ª Escola Diocesana de Formação de Assessores no ano de 2008. Ela foi realizada em oito etapas no período de dois anos. Depois disso, outra turma foi formada no ano de 2011 através de seis etapas, tendo como temática principal a formação bíblica, e a terceira turma foi formada nos anos de 2017 e 2018 em seis etapas.
Houve eventos importantes realizados no Brasil que contaram com a presença da PJ de nossa Diocese: o Encontro do Papa Bento XVI com a juventude no dia 10 de maio de 2007 no estádio do Pacaembu, em São Paulo, e a Jornada Mundial da Juventude realizada no Rio de Janeiro, em julho de 2013. Nestes eventos, não apenas a PJ, mas todas as expressões juvenis da Diocese se fizeram presentes.
Agora, no ano de 2023, podemos comemorar os 50 anos dessa história, e alguns jovens da Diocese puderam estar presentes em Aparecida (SP). Esse encontro teve a presença de jovens pejoteiros de todo o Brasil. Também marcaram presença nomes muito importantes para a PJ no Brasil, como Carmem Lúcia Teixeira e o Pe. Jorge Boran. Fomos presenteados com uma carta do Papa Francisco. Esse foi um momento de muita celebração.

Esperamos poder comemorar muito mais anos de PJ na nossa Diocese com muita caminhada, força e trabalho.
Flavia BarbosaNeste mês missionário nos dedicamos a refletir sobre nossa missão de levarmos Jesus ao mundo inteiro. Em especial, destacamos a Virgem Maria como modelo desta missão, pois foi por ela que o mesmo Jesus desceu até nós. Surge, assim, uma boa ocasião para conhecermos ela melhor, ainda mais porque temos uma grande festa mariana no dia 12 de outubro: a Festa de Nossa Senhora Aparecida.
Nossa Catequese a respeito da pessoa e missão de Maria é muito bela, pois os textos bíblicos que tratam do tema são muito profundos e a Igreja soube, à luz de sua Tradição, compreendê-los sempre mais. Vamos, então, nos aprofundar em dez fatos a respeito da Virgem Maria que nos ajudam a entender o que esta mulher tem de tão especial a ponto da Bíblia dizer que ela é “Bendita entre as mulheres” (Lc 1,42).
Na eternidade, Deus decidiu enviar seu Filho ao mundo e, ao fazer isso, decidiu como seria a mulher pela qual Ele nasceria entre nós. Pensou em como seria Maria, suas qualidades e sua santidade. Muitos séculos antes de Jesus vir ao mundo, Deus o anunciou e nos deu uma primeira característica daquela que seria sua mãe: “Eis que a virgem ficará grávida e dará à luz um filho, e o nome d’Ele será Emanuel, Deus Conosco” (Is 7,14).
Depois que nossos primeiros pais, por livre escolha, caíram no pecado, eles começaram a transmitir uma mancha de pecado para seus filhos, o
chamado “pecado original” que faz com que nasçamos com uma tendência ao pecado. Para ser uma digna Mãe para o Filho de Deus, o Pai quis que Maria não fosse contaminada com essa mancha. Assim, no primeiro instante que ela foi concebida no ventre de Ana, Deus a preservou de ser atingida por essa mancha. Por isso chamamos Maria de “imaculada”. Depois disso, Maria viveu em plena santidade e jamais cometeu um único pecado. Por isso, pode de um modo pleníssimo ser chamada “cheia de graça” (Lc 1,28).
Por ser Filho de Deus, o Pai quis que Maria concebesse de uma forma milagrosa, sem a ajuda de homem algum. Assim uma obra extraordinária do Espírito Santo fez com que o óvulo de Maria se transformasse no embrião de Jesus.

Durante o parto de Jesus, Deus não quis que seu Filho nascesse causando dor e machucando Maria, assim fez com que Jesus saísse de dentro do ventre
dela de forma milagrosa. Como? Podemos comparar ao modo pelo qual Jesus entrou no cenáculo, estando as portas fechadas ou como a luz atravessa o vidro sem precisar quebrá-lo.
Depois do parto de Jesus, o ventre de Maria era sagrado. Maria manteve-se a vida inteira sem realizar nenhum ato conjugal com São José. Deus quis que fosse assim para testemunhar eternamente o fato de que Jesus era seu próprio Filho. Não é sem razão que, ao falar de Maria, a Bíblia enfatiza a palavra “virgem” (até mesmo duas vezes num único versículo, conforme Lc 1,27).
4ª O CORPO FOI LEVADO POR
Uma consequência do pecado é esta: “És pó e ao pó voltaras” (Gn 3,19).
Agora pense: “Se o corpo apodrecer é uma consequência do pecado e Maria nunca pecou, faria sentido o corpo dela apodrecer”? É claro que não. Por isso Deus quis que após o término dos dias dela nesta terra, que subisse em corpo e alma para o céu. Os outros santos,
“Estes fatos a respeito de Maria colocam luz sobre nossa vida também, pois ela foi colocada por Deus como um exemplo a ser seguido por nós. Que do alto céu ela interceda por nós e nos ajude a sermos melhores missionários de seu Filho, coisa que só será possível se primeiro formos bons discípulos”.
como São Pedro, Santa Luzia estão no céu só com suas almas e somente no fim dos tempos é que Deus vai ressuscitar seus corpos, mas Maria não. Os anjos já a levaram para o céu em corpo e alma.
No Povo de Deus, na dinastia de Davi, quem reinava junto com o rei não era sua esposa, mas era sua mãe (1Rs 2,19), e Jesus é o Rei do céu e da terra, seguindo a dinastia de Davi. Assim sua mãe se tornou também Rainha do céu e da terra. Também porque ela participou da Salvação do mundo ao aceitar ser a mãe do Salvador do mundo. Deste modo, Jesus quis glorificá-la fazendo-a participante de sua glória. Leia Apocalipse e veja o sinal da Mulher, glorificada e coroada, simbolizando a glória e coroamento de toda a Igreja, bem como de Maria (cf. Ap 12, 1).
Por ser a Mãe de Jesus e pelo fato de que todos os homens devem estar unidos a Jesus, Deus Pai quis que Maria se tornasse mãe de todos nós. Maria é a nova Eva e a palavra Eva significa “mãe dos viventes”. Foi Jesus mesmo quem nos colocou aos cuidados de Maria: antes de morrer crucificado. Ele olhou para Maria e disse a cada um de nós, representados pela pessoa do discípulo amado: “Filho eis aí a tua mãe!” (Jo 19,26). Maria ama você como um filho. E você? Você ama Maria como uma mãe?
Já vimos que Maria está em corpo e alma no céu e Deus transformou ela em uma mensageira d’Ele. De tempos
em tempos, Deus faz com que Maria apareça em algum lugar do mundo e transmita uma mensagem, pedindo a conversão dos homens. E ela faz vários milagres e sinais para que os homens saibam quem verdadeiramente é ela.

Quer saber mais uma curiosidade? Para mostrar ainda melhor que é nossa mãe, Maria surge parecida com seus filhos. Assim, quando apareceu em Akita, no Japão, Maria tinha o rosto parecido com uma mulher japonesa; quando apareceu no México, ela parecia uma índia mexicana.
Para distinguir as aparições umas das outras, nós usamos títulos diferentes relacionados ao lugar ou modo da aparição, por exemplo, Nossa Senhora de Lourdes para quando ela apareceu para Bernadete na Vila de Lourdes (França). Mas sempre é a mesma mulher: Maria, a mãe de Jesus. Assim como o mesmo Jesus tem vários títulos diferentes: Messias, Senhor, Salvador, Príncipe da Paz, etc.
A Bíblia nos manda interceder uns pelos outros (Tg 5,6), isto é, pedir a Deus pelo bem das outras pessoas. E lá no céu, os santos também podem rezar, e lemos em Apocalipse a alma dos mártires rezando diante do trono de Deus (Ap 6,9-10). Assim Maria, que muito nos ama, reza por nós diante de Deus. E tanto mais pedimos isso, tanto mais ela o faz. Por isso pedimos: “Rogai por nós”.
Nós católicos cumprimos muito bem essa profecia que está lá no Evangelho de Lucas, quando o Espírito Santo faz Maria cantar: “Desde agora, me proclamarão bem-aventurada todas as gerações” (Lc 1,48).
A oração da Ave-Maria está na Bíblia. Deus mandou o Anjo dizer a Maria: “Ave, cheia de graça, o Senhor é contigo” (Lc 1,28); e o Espírito Santo fez Isabel dizer: “Bendita és tu entre as mulheres e bendito é o fruto do teu ventre” (Lc 1,42) e chamá-la “Mãe do meu Senhor (Deus)” (Lc 1,43). Depois de louvá-la, pedimos a intercessão dela, assim como muitas vezes os cristãos pediram a intercessão de outros cristãos (Ef 6,19).
A Bíblia louva várias virtudes de Maria que nós devemos ter também:
Sua fé: “Bem-aventurada és tu que creste” (Lc 1,45). Maria acreditava em tudo que Deus revelou. Devemos crer também, pois Deus só conhece e só diz a verdade, aliás, Ele é a própria Verdade.
Sua obediência: “Eis aqui a escrava do Senhor. Faça-se em mim segundo a tua Palavra” (Lc 1,38). Como Maria, devemos sempre obedecer a Deus sabendo que tudo que Ele nos pede é para a nossa maior felicidade.
Sua humildade: “Olhou para minha humildade” (Lc 1,48). Embora fosse a mulher mais gloriosa da terra, Maria era uma mulher humilde que não queria ser maior que ninguém e a todos tratava com grande respeito. Nós também precisamos ser assim, nos vendo como servos de Deus, semelhantes aos demais e a serviço d’Ele.
Sua caridade fraterna: “Maria se levantou e foi às pressas... entrou em casa de Zacarias e saudou Isabel” (Lc 1,39-40). Esta passagem que Maria vai ajudar a parente grávida e a passagem em que se preocupa com a celebração do casamento dos noivos mostram que Maria era uma mulher prestativa, sempre disposta a ajudar quem precisava dela. Nós devemos ter esta boa disposição também.
Sua meditação sobre o amor de Deus: “Maria conservava todas estas palavras, meditando-as no seu coração” (Lc 2,19). Maria se lembrava e pensava em Deus constantemente, assim nós devemos nos lembrar d’Ele e pensar n’Ele muitas vezes por dia, pois Ele está conosco a todo momento.
Todos estes fatos a respeito de Maria colocam luz sobre nossa vida também, pois ela foi colocada por Deus como um exemplo a ser seguido por nós. Que do alto céu ela interceda por nós e nos ajude a sermos melhores missionários de seu Filho, coisa que só será possível se primeiro formos bons discípulos. Maria nos ensina: “Fazei tudo o que Ele vos disser” (Jo 2,5).
Pode-se dizer que a vida vocacional de Pe. Solano Alcioni Tambosi é um grande exemplo de testemunho vocacional e de entrega a serviço de Deus presente em nossa Diocese. Nascido em Rodeio (SC) em 19 de maio de 1957, é filho de Conrado Tambosi e Inês Longo Tambosi (ambos em memória). Possui sete irmãos, sendo quatro homens e três mulheres, dentre eles o mais velho já falecido. Seus pais trabalhavam e ganhavam a vida como agricultores já que na região onde moravam era comum o plantio de arroz do banhado. Sua mãe, Inês Longo Tambosi, era também costureira.

Tanto sua infância como sua adolescência sempre foram marcadas pela vida na comunidade da Igreja, pois sua família era muito participativa. Pe. Solano estudou no Colégio Osvaldo Cruz que na época era dirigido pelas irmãs catequistas Franciscanas, cuja ordem nasceu em Rodeio (SC). Muitas delas também foram suas professoras, o que por sua vez acabou ampliando ainda mais a vida e visão de Igreja que ele tinha.
Ainda em sua infância ele conheceu os missionários capuchinhos que estiverem em sua paróquia e por serem muito carismáticos, os freis conseguiam motivar e trazer as pessoas para os grupos na comunidade e acabaram despertando no jovem Solano o desejo de seguir a Jesus, e foi aí que se manifestou o primeiro desejo de ser um sacerdote.
Ainda em sua infância, seu irmão Danilo, que era o quinto filho de seus pais, ingressou no Seminário do Verbo Divino de Santa Catarina. Foi assim que o jovem Solano, ao visitar o irmão no seminário, conheceu o Pe. Agostinho que era um dos sacerdotes do Verbo Divino, outra figura que também despertou o seu desejo de se tornar padre. É importante ressaltar que a sua devoção a Nossa Senhora e a participação nas missas e grupo de jovens o ajudaram a alimentar ainda mais este desejo e sempre mantê-lo vivo.
Quando decidiu ingressar no seminá-
rio foi falar com o Pe. Agostinho que o levou até Curitiba para conhecer o seminário dos missionários do Verbo Divino. No ano seguinte, em 1979 ingressou no seminário onde cursou Filosofia e terminou no ano de 1981. Fez o noviciado em Miracatu (SP) onde ficou por um ano e fez seus primeiros votos. Ainda em São Paulo, Pe. Solano cursou Teologia onde ficou por quatro anos, período marcado pelas experiências pastorais que havia tanto no seminário como também nas férias, experiências essas que marcaram sua formação.
No dia 29 de novembro de 1986, concluído o curso de Teologia, o seminarista Solano foi ordenado sacerdote na cidade de Rodeio (SC), e no dia seguinte celebrou sua primeira missa.
Seu primeiro destino para o exercício de seu ministério foi na Paróquia São João Batista, em Foz do Iguaçu, onde ficou por dois anos junto ao Pe. Germano, que o ensinou muito em seus primeiros anos como sacerdote. Depois destes dois anos foi transferido para Curitiba para trabalhar na Pastoral Vocacional, e neste tempo percorria as paróquias que estavam situadas no Paraná, Santa Catarina e Mato Grosso do Sul.
Foi na Pastoral Vocacional que Deus utilizou Pe. Solano como um instrumento, já que pode ver os frutos de seu trabalho quando 18 dos que encaminhou para o seminário se tornaram sacerdotes, e trabalham por diferentes partes do Brasil. Depois de quatro anos na Pastoral Vocacional foi, então, desig-
nado para Toledo no ano de 1994 para trabalhar no Seminário do Verbo Divino, que era a etapa propedêutica, na época com 25 seminaristas que já haviam terminado o ensino médio. Neste período teve muito trabalho já que estava sozinho como formador, administrador e diretor espiritual, além de também ser vice provincial dos missionários do Verbo Divino na Região Sul. Mas com a graça de Deus pode superar tudo isso. Depois de dez anos percebeu que estava sendo chamado para a vida diocesana. Ainda quando estava como reitor do seminário, passou também a ajudar o Pe. Daniel Hemkemeier, já falecido, na Paróquia São Francisco de Assis, onde no ano de 2000 assumiu como pároco. Em 2004, Pe. Solano ficou por seis meses com o Pe. Lucas Schwarz na Paróquia Sagrado coração de Jesus, em Marechal Cândido Rondon, para fazer seu primeiro contato com a Diocese e, no ano seguinte, em 2005 foi nomeado pároco da Paróquia Santa Rosa de Lima, de Nova Santa Rosa, onde fez muitas amizades e experiências.
No entanto, não ficou por lá muito tempo e em 2006 foi transferido para a Paróquia Sagrado Coração de Jesus, de Marechal Cândido Rondon, onde além de assumir a paróquia também, a pedido de D. Francisco Carlos Bach (5º bispo diocesano), ficou responsável pelo Colégio Cristo Rei. Nos anos em que esteve em Marechal exerceu muitos trabalhos, pois tinha que conciliar a paróquia com o colégio que na época estava falido e sucateado, e que com a graça de Deus pode fazer um grande trabalho nos 14 anos que ali ficou.
Nestes anos que ficou na Paróquia Sagrado Coração de Jesus, alguns padres estiveram também com ele, como o Pe. Vanderlei Ghelere, Pe. Sérgio Augusto Rodrigues, Pe. Jauri Strieder, Pe. Marcelo Ribeiro da Silva e Pe. Leandro Fazolini, com todos eles pode ter um espírito de unidade. Em 2021, Pe. Solano foi transferido para a Paróquia Nossa Senhora de Lourdes, de Tupãssi, onde
“Levando em consideração sua biografia e seu lema de ordenação “Eu, porém, estou no meio de vós como aquele que serve” (Lc 22,27), podemos concluir que representam ao Pe. Solano o desejo e amor pela vida de serviço a Deus e entrega total ao próximo. Um exemplo disso é quando assume uma comunidade e na missa de posse sempre diz a frase: ‘Estou aqui para amar vocês e quando nós apenas amamos não tem o que dar errado, pois é isto também que Jesus nos ensinou’”.
Sou Daniel Rosa Brasil, tenho 20 anos e estou no Seminário Maria Mãe da Igreja, em Toledo. Sou filho de Adelar Brasil e de Maria Helena Rosa. Sou natural da cidade de Tupãssi, especificamente, do Distrito de Jotaesse.

Minha história vocacional começou no ano de 2017 quando, por meio da Pastoral Vocacional, fui convidado pela primeira vez para conhecer o seminário. A equipe fez uma visita na escola e convidou os rapazes a participarem de um Domingão Vocacional, que aconteceria no Seminário São Cura d’Ars, em Quatro Pontes, onde poderíamos conhecer uma casa de formação, além de participar das atividades e gincanas que aconteceriam no final de semana.
Porém, aquele ano não fui, mas fiquei com uma curiosidade depois que alguns colegas de classe comentaram sobre como foi conhecer o seminário. Em 2018, novamente fui convidado por um amigo que já havia conhecido no ano anterior. Naquele ano fui participar do encontro, porém ainda fiquei com a curiosidade de conhecer melhor o seminário e rotina dos seminaristas. Foi então que, no final do encontro, o Pe. Marcelo Ribeiro da Silva, que atualmente é o reitor do Seminário Menor em Quatro Pontes, fez um convite aos jovens que tinham 14 e 15 anos a participarem do Pré-seminário, onde ficaríamos dois dias para conhecer melhor a rotina na casa de formação.
Ainda em 2018 comecei a fazer as etapas do Pré-seminário, mas sem a intenção de ingressar. No decorrer daquele ano fui fazendo todas as etapas, e quando chegamos na penúltima comecei a refletir mais sobre minha vocação e me perguntar se a vocação sacerdotal era para mim. Em torno de dois meses, até a última etapa, pensei sobre a possibilidade de entrar no seminário.
diz estar muito feliz.
Segundo as palavras do Pe. Solano, “todos os lugares em que estive sempre houve dificuldades, porém, se queremos superá-las e amadurecer só existe um remédio: a Palavra de Deus, a oração e a entrega de nossa vida a Deus”. E hoje ele é feliz em sua vocação como sacerdote por poder estar perto de Deus e da comunidade e poder servir, especialmente, os doentes e os mais sofredores.
Portanto, levando em consideração tudo o que foi dito até agora a respeito da vida vocacional de Pe. Solano podemos concluir que seu lema de ordenação “Eu, porém, estou no meio de vós como aquele que serve” (Lc 22,27), expressa este desejo e amor pela vida de serviço a Deus e entrega total ao
O que me ajudou, de fato, a decidir ingressar no seminário foi a oração. Sempre que estive em dúvida, a coloquei diante de Deus e, com certeza Ele me ouviu. Decidi que entraria ao seminário no último encontro, depois que conversei com o Pe. Marcelo. Ingressei, então, no ano de 2019, onde fiz o 2º e 3º ano do ensino médio.
Claro que tudo isso só aconteceu pelo apoio que tive de minha família que desde o início esteve junto na minha decisão, e pelo fato que desde a infância fui motivado por meus pais a participar das celebrações.
Portanto, posso dizer que hoje, depois de quatro anos, já na etapa do Discipulado no Seminário Maria Mãe da Igreja, estou feliz pelo sim que disse a Deus anos atrás, tanto para conhecer o seminário como também para fazer parte da formação para sacerdote. Espero que, de fato, esta seja a minha vocação de serviço a Deus e a seu Reino.

Por fim, posso dizer que se não tivesse primeiramente tomado a decisão de somente conhecer o seminário não teria feito uma grande experiência como fiz, estando no seminário todos estes anos.
próximo. Um exemplo disso é quando assume uma comunidade e na missa de posse sempre diz a frase: “Estou aqui para amar vocês e quando nós apenas amamos não tem o que dar errado, pois
é isto também que Jesus nos ensinou. Portanto, que possamos aprender com o Pe. Solano, também a amar e entregar a Deus as nossas dificuldades e angústias.
Este mês de outubro, quando se comemora em concomitância o dia dedicado à Padroeira do Brasil, Nossa Senhora Aparecida, e o Dia das Crianças, mostra-se momento apropriado para a reflexão acerca desse tema que, em sua base, move a atividade evangelizadora cursilhista. As crianças simbolizam a esperança de uma vida nova e repleta de possibilidades, a esperança de uma vida eterna que fundamenta o viver cristão.
Durante nossa recente Escola Vivencial Diocesana, o Movimento de Cursilhos de Cristandade da Diocese de Toledo foi agraciado com a mensagem do Pe. Valtuir Bolzan, de Getúlio Vargas (RS), com o tema “Esperança no Cursilho”. Com seu característico bom humor e espontaneidade, o Pe. Bolzan trouxe uma inspiradora fala acerca da importância da compreensão da esperança como base de nossa fé e da necessidade da ação evangelizadora cursilhista.

O mensageiro levou a assembleia à uma viagem reflexiva que abordara os passos trilhados desde a iniciação da fé cristã até a experiência do encontro consigo mesmo, com Cristo e com a comunidade, na qual a esperança no anúncio feito pelo Messias é vivenciada. Com um falar aconchegante, Pe. Bolzan relatou sua experiência única com Cristo durante os três dias em que participou do seu retiro e as singularidades que guardam esse momento, as quais

fizeram o sacerdote reservar um lugar especial para o Cursilho em seu coração.
Com a simplicidade e a humildade que lhe são inerentes, Pe. Valtuir Bolzan cativou os presentes e conduziu-os à recordação da experiência de três dias que, certamente, possui um lugar especial reservado em suas memórias. É dominante o sentimento de que essa recordação propiciou rememorar o chamado que foi feito a cada neo-cursilhista, de tomar a sua cruz e seguir a Cristo, de responder ao sinal. E a experiência do 4º dia encontra sua expressão na vivência do martírio.
O martírio de Cristo foi sacrifício de amor máximo, pleno e representa ícone de inspiração à assunção do martírio
branco, cotidiano, que a experiência do retiro nos conclama a vivenciar, cujo fundamento se sustenta na esperança em Cristo Ressuscitado. Sim, o exemplo máximo de Jesus em sua passagem pela Terra é guia irretocável de santidade e viver edificante. Entretanto, é sua ressureição que alicerça a fé em seu anúncio e solidifica a esperança na vida eterna.
“Pois temos ouvido falar da fé que vocês têm em Cristo Jesus e do amor que têm por todos os santos, por causa da esperança que está reservada a vocês nos céus, a respeito da qual ouviram por meio da palavra da verdade, o evangelho” (Cl 1,4-5). O amor a Cristo e a tudo que foi agraciado por Ele são marcas do verdadeiro cristão e o viver desse
“É com a alegria e a força da esperança em Cristo que o cristão cursilhista acolhe o chamado ao martírio, a missão de testemunhar Jesus e a Palavra de Deus com coragem, entusiasmo e vivência cristã sinodal. A confiança no anúncio e a alegria que dela decorre são características que identificam o cursilhista e são pressupostos da verdadeira fé na Santa Aliança”.
A vida terrena na graça está alicerçada na certeza da esperança da eternidade1º/10 Almoço no Carta (responsável: equipe de Marechal Cândido Rondon)
3/10 Escola Vivencial Diocesana Assis Chateaubriand

7/10 3º Concurso da Galinhada Assis Chateaubriand
10/10 Escola Vivencial Setor Marechal Cândido Rondon
“Portanto, visto que temos tal esperança, mostramos muita confiança” (2Cor 3,12). É com a alegria e a força da esperança em Cristo que o cristão cursilhista acolhe o chamado ao martírio, a missão de testemunhar Jesus e a Palavra de Deus com coragem, entusiasmo e vivência cristã sinodal. A confiança no anúncio e a alegria que dela decorre são características que identificam o cursilhista e são pressupostos da verdadeira fé na Santa Aliança.
19 a 22/10 98º Cursilho – Masculino
26 a 29/10 98º Cursilho – Feminino
1º/11 Encontro de Acolhida 98º Cursilho Assis Chateaubriand
5/11 Almoço no Carta (responsável: equipe de Toledo)
7/11 Escola Vivencial Diocesana

anúncio é a identidade do cristão cursilhista. A esperança da vida celeste, eterna e plena, junto do
Senhor, é parte essencial do fundamento da fé católica e da felicidade genuína do viver cristão.
“Antes, santifiquem Cristo como Senhor em seu coração. Estejam sempre preparados para responder a qualquer pessoa que pedir a razão da esperança que há em vocês” (1Pd 3,15). E que outra razão há para a esperança que habita o alegre e confiante coração do cristão cursilhista senão a ressureição em Cristo? Há, ainda, algum outro estudo que mereça mais atenção que este? Há outro saber que transcende esta vida?

“Alegrem-se na esperança, sejam pacientes na tribulação, perseverem na oração” (Rm 12,12). A Sagrada Escritura guia a vivência do martírio daquele que tem esperança no Senhor e, portanto, fala com Ele.
“Ele o fez a fim de que, justificados por sua graça, nos tornemos seus herdeiros, tendo a esperança da vida eterna” (Tt 3,7). A passagem da epístola do Padroeiro do Movimento de Cursilhos de Cristandade, São Paulo Apóstolo, traduz a essência da verdadeira felicidade cristã e o fundamento do agir cursilhista: a vida terrena na graça alicerçada na certeza da esperança da eternidade. O assumir do compromisso com o martírio proposto por Cristo e o partilhar da existência em sinodalidade são os caminhos propostos nesse movimento de justificação pela graça e pelo esperar da vida eterna.
Marcos Hawerroth, Josiane Bucalão, Rafael Hirata e Giani Verdi Cursilhistas da Diocese de Toledo
Pelo segundo ano consecutivo, o Sicoob – instituição financeira cooperativa que integra 338 cooperativas singulares, 14 centrais e o Centro Cooperativo Sicoob (CCS), atendendo a 7,5 milhões de cooperados e 1,5 milhão de não-cooperados –, conquistou um lugar de destaque em premiação de grande relevância no mercado financeiro. Desta vez, o Valor 1000 posicionou a entidade entre os Top 10, na categoria “100 maiores bancos” do País.
Esse levantamento é realizado anualmente pelo jornal Valor Econômico em parceria com a Serasa Experian e a Escola de Administração de Empresas de São Paulo da Fundação Getúlio Vargas (FGV), o que reforça sua credibilidade.

O desempenho do Sicoob evidencia, na prática, o notável crescimento das cooperativas nos últimos anos. Hoje, são mais de 4,5 mil pontos de atendimento físico, complementados por investimentos robustos no digital. Essa abrangência nacional reflete o compromisso das cooperativas com um serviço de excelência, ampliando a participação da população brasileira no cooperativismo financeiro.
No ranking, o Sicoob ocupa a 9ª posição, com R$ 237,6 bilhões em ativos, número que demonstra um aumento significativo de 24,8% em relação ao ano anterior. Além disso, a carteira de crédito superou R$ 140,5 bilhões, tendo apresentado o maior crescimento (22,4%), em comparação a 2021, entre as 10 maiores instituições financeiras brasileiras.
“Esse crescimento, especialmente em relação à carteira de crédito – o mais expressivo entre os principais atores do mercado financeiro –, demonstra o compromisso inequívoco que as cooperativas do Sicoob têm em apoiar os cooperados. Sempre buscamos manter um contato mais próximo com o nosso público assegurando atendimento digno e condições justas, pois os cooperados são os verdadeiros donos do negócio. E o Sicoob, como instituição financeira cooperativa, representa uma alternativa genuína e autêntica para uma relação mais saudável com o dinheiro”, diz Ênio Meinen, diretor de Co-
De acordo com informações do Banco Central, as cooperativas financeiras aumentaram sua representatividade no Sistema Financeiro Nacional até o final 2022, mantendo-se como o segmento com maior expansão de crédito.
“Estamos testemunhando um cenário de crescimento do cooperativismo financeiro no Brasil. Dados recentes do Banco Central, por exemplo, refletem claramente nossa trajetória ascendente no Sistema Financeiro Nacional, demonstrando que continuamos a ser um setor de destaque, sobretudo em termos de inclusão financeira e expansão de crédito, em cuja operação o conjunto do segmento, no último ano, avançou 21,5% contra 14% da média do mercado”, destaca Ênio.
O Sicoob se destaca ao desempenhar um papel fundamental no suporte e fomento às atividades econômicas
Na carteira de crédito (com um saldo de R$ 140,5 bilhões), o Sicoob ficou na 8ª posição no ranking, mesma posição ocupada em depósitos (somando R$ 147,8 bilhões). Em patrimônio líquido (totalizando R$ 37,9 bilhões) e resultado líquido (de R$ 7,2 bilhões), ocupou a 7ª colocação. Outro destaque foi a 8ª colocação com receitas de intermediação (R$ 31,3 bilhões) e a 6ª em melhor resultado operacional
locais em diversas regiões do Brasil. “Em muitas dessas localidades, as cooperativas que integram o Sicoob representam o acesso mais próximo e, não raro, único aos serviços financeiros para indivíduos e empreendedores, contribuindo diretamente para a promoção da cidadania e justiça financeiras e o desenvolvimento sustentável dessas comunidades”, finaliza o executivo.
sem a equivalência patrimonial (R$ 7,6 bilhões).
O Sicoob também está na 7ª colocação entre as 20 instituições mais rentáveis sobre o patrimônio médio (21,2% do PL médio). Além disso, com sua operação própria de seguros de vida, a instituição financeira destacou-se mais vez, garantindo a 23ª posição no ranking “maiores em Vida e Previdência”.


O Governo do Estado, por meio da Secretaria da Saúde (Sesa), formalizou juntamente com os municípios do Paraná o compromisso para uma mobilização estadual de imunização: o Dia D de multivacinação para toda a população. A data estipulada é 21 deste mês de outubro, dia para um grande chamamento dos paranaenses. A campanha iniciará dia 14 e vai até dia 28.
O objetivo da iniciativa é aumentar a cobertura vacinal no Estado. O compromisso está firmado entre a Sesa e o Conselho das Secretarias Municipais de Saúde (Cosems/PR).
Para o diretor-geral da Sesa, César Neves, a participação de todos, em um trabalho conjunto, é fundamental para a tomada de decisões e o resultado das pactuações afetam diretamente a população. “Todos participando para um objetivo só, que é aumentar nossa cobertura vacinal, que já foi uma das melhores do País e referência. Todas as vacinas estarão disponíveis e contamos com todos os profissionais, gestores e a população para um grande dia”, disse.
De acordo com um levantamento da Sesa, 669 mil doses da vacina contra a Influenza, por exemplo, estavam disponíveis em agosto nos municípios para a população em geral.

Para a diretora de Atenção e Vigilância, Maria Goretti Lopes, responsável pela área da Imunização da Sesa, a campanha é mais um reforço e um alerta para a população estar em dia com a vacinação. “A iniciativa é em conjunto com o Ministério da Saúde, estados e municípios, em uma grande ação nacional. Agradecemos muito a todos que irão participar, desde o pequeno até ao maior município”, enfatizou.
Dentro da demanda das Linhas de Cuidado (materno-infantil, idoso e pessoa com deficiência), foi apresentada e firmada durante a 4ª Reunião Ordinária da Comissão Intergestores Bipartite (CIB/PR) a agenda com as ações neste
segundo semestre para um grande avanço na estratégia estadual “Envelhecer com Saúde no Paraná”. Entre elas estão a criação de uma nova forma de abordagem e estratégias de avaliação da pessoa idosa.
“Estamos aqui pela quarta vez neste ano, alinhando novas ações, confrontando ideias. É muito importante esse momento para os municípios do Paraná. Alguns assuntos demandam tomada de decisão rápida e assertiva, e é nesse momento aqui que podemos trazer soluções para os municípios”, afirmou o presidente do Cosems e secretário municipal de Saúde de Mangueirinha, Ivoliciano Leonarchik.
Como assunto permanente, o cuidado da gestante terá uma atenção especial e mais direcionada ainda. Foi acordada a criação de um grupo especializado
para acompanhar as demandas municipais onde os índices de mortalidade infantil estão abaixo do esperado. Houve, ainda, discussão sobre a importância do programa de incentivo financeiro para a reabilitação de deficiência intelectual.
Finalizando a pauta da reunião da CIB/PR, foram definidas ações estratégicas para enfrentamento de doenças crônicas e agravos não transmissíveis, a alteração do fluxo de priorização e autorizações dos procedimentos cirúrgicos e o debate sobre a importância de novas ações para o combate das arboviroses no Paraná.



O nosso secretário de Pastoral, coordenador diocesano da Animação Bíblico-catequética e representante comercial da Revista Cristo Rei, Fernando da Rocha, virou notícia. Na verdade, não ele, mas a família de Fernando que aguardava com a esposa Aline e o primogênito Paulo a chegada de Helena. E a Revista Cristo Rei compartilha contigo essa informação enviada pela assessoria de Imprensa do Hospital.
Helena Rocha nasceu no dia 20 de setembro de 2023 na Hoesp/Hospital Bom Jesus e no dia seguinte já tinha a Certidão de Nascimento emitida. Agora o documento pode ser feito na Hoesp, através da parceria com o 3º Tabelionato
de Notas e Registro Civil de Toledo. Os pais apresentaram os documentos necessários e em cerca de dez minutos já estavam com a certidão em mãos. “Estávamos preocupados em fazer o registro no cartório, não sabia se meu marido poderia ir sozinho, e quando iríamos, até porque eu fiz uma cesárea, e, portanto, a locomoção não é tão fácil “, diz a mãe da Helena, Aline da Rocha.
Esse é o segundo filho do casal, que também nasceu na Hoesp. O pai, Fernan-
do Rocha, conta que o registro do primeiro filho demorou mais tempo para ser feito. “Gostamos muito que agora pode ser feito enquanto estamos no hospital, facilita muito e economiza tempo”, diz.
Os documentos necessários para fazer o registro são RG, CPF e a declaração de nascido vivo, fornecida pelo próprio hospital. A Certidão de Nascimento é gratuita e os pais já saem com o documento impresso. “Sair com a Certidão de Nascimento do hospital facilita muito para os pais que nesse momento se dedicam ao cuidado com o recém-nascido e recuperação das mães”, ressalta a superintendente, Zulnei Bordin.
O cartório estará fazendo os registros no hospital todos os dias no período da manhã, a partir das 9h, exceto fim de semana.
O Governo do Estado divulgou em Audiência Pública o Plano Plurianual 2024-2027 (PPA) do Paraná. O documento é importante instrumento de planejamento em médio prazo. A secretaria de Planejamento estima uma aplicação de R$ 250 bilhões em obras e demais investimentos em quatro anos. O PPA segue para Assembleia Legislativa onde os deputados terão a oportunidade de analisar, visando a inclusão de emendas e aprovação. Após votado, o Plano dará a diretriz orçamentária ao Estado.
Algumas demandas constam no Plano Plurianual e estão relacionadas à moradia popular, smart cities (cidades inteligentes), metodologia para medir resultados, estradas rurais, concursos públicos, formação superior, mobilida -
- Restauração e ampliação da capacidade de tráfego das rodovias PR-239 e PR-317, no trecho e Assis Chateaubriand-Toledo, extensão aproximada de 44,3 quilômetros
- Construir a Delegacia Cidadã em Toledo (Padrão III, com área aproximada de 1.800 m²) e em Assis Chateaubriand (Padrão 1A, com área aproximada de 370m²)
- Construir novas sedes do 19º Batalhão de Polícia Militar (2.500 m²),
de, integração de trabalhadores idosos, tecnologia, segurança, vulnerabilidade
no município de Toledo; sede do 31º Batalhão de Polícia Militar (2.600m²), no município de Assis Chateaubriand; sede do Batalhão de Polícia da Fronteira BPFRON, no município de Marechal Cândido Rondon (6.000 m²)
- Construção de novas unidades habitacionais ou melhorias ou reformas, para famílias do meio urbano de Toledo e de Guaíra
- Restauração da Rodovia PR-182, no trecho Francisco Alves-Palotina
social e ampliação da participação de mulheres.
A ganhadora, que é professora, fez um depósito a prazo no início da campanha, em março
A 2ª edição da Promoção Aplicação Premiada da Sicredi Progresso PR/SP encerrou-se na manhã da última quinta-feira (14) com sorteio do Honda New HR-V 0km, que saiu para a professora Marinez Grando Muller, de Toledo. Ela foi a 24ª ganhadora da campanha que sorteou quase R$ 500 mil em prêmios durante o ano.

A ganhadora é professora na rede municipal e associada da Agência Coopagro, onde abriu conta em 2010 e, este ano, por incentivo do gerente resolveu fazer a aplicação por depósito a prazo, ainda em março. “Ele me orientou a fazer o depósito por saber que eu tinha dinheiro parado na conta e segui o conselho. Rendeu muito ter feito a aplicação, afinal, não é todo dia que recebo uma ligação dizendo que ganhei um carro”, brinca Marinez.
Valmir Jose Kozik, gerente da agência Coopagro, foi quem ligou para a contemplada para dar a notícia. Surpresa, a professora não acreditou imediatamente. “Fiquei surpresa e desconfiada, pois não lembrava que estava concorrendo ao sorteio. Estou muito feliz, ainda processando tudo.” Marinez também enfatizou que a relação de confiança e proximidade é um dos motivos que a fez confiar na cooperativa para investir. “É um relacionamento muito próximo, trocamos áudios sempre que necessário e meu gerente me explica sobre o que tenho dúvida. É um diferencial e um relacionamento de muita confiança no Sicredi”, assegurou.
Kozik comemora com a ganhadora.
“Somos ‘pé quente’ e ficamos felizes que ela tenha ganhado o prêmio de maior valor da Promoção. Os associados da Coopagro são merecedores. Agradecemos a confiança de todos e que isso possa fortalecer ainda mais o bairro, a agência e nossa cooperativa como um todo.”
A gerente de Desenvolvimento de Negócios, Thais Hermisdorff Amaral, avalia a 2ª edição da Promoção como muito positiva e lembra que o objetivo também é incentivar os associados a realizarem investimentos. “Estamos gerando essa cultura, dado que é um investimento rentável, de baixo risco e que, na nossa cooperativa, ainda dá a chance de concorrer a prêmios. Ficamos muito contentes com a adesão das agências e dos associados que já esperavam pela 2ª edição. Nesse ano, foram dois veículos sorteados, um a mais que no ano passado”, lembrou.
A Diretora de Negócios da Sicredi Progresso, Carina Vargas, participou da entrega e comentou porque é importante a Promoção. “Queremos despertar essa consciência para investimentos e mostrar para a comunidade que o Sicredi é uma instituição de investimentos segura, além de reforçar nosso patrimônio porque é também por meio dessas aplicações que o associado soma aos
resultados, gerando fundos, aumentando a carteira de crédito e fazendo todos crescerem. Qualquer investidor, do pequeno ao grande, pode trazer seu dinheiro, ter rentabilidade e, ainda, concorrer a prêmios. É uma satisfação para todos nós podermos ver a reação dos associados, assim como a Marinez ao ganhar, ela que movimenta a conta, investe e que certamente merece esse prêmio”, conclui.
Ao todo foram 22 sorteios de R$ 10 mil e dois veículos. A Chevrolet Tracker 0km foi sorteada em junho, para Nildo Valentin da Costa. A divulgação do último sorteio foi realizada na sede administrativa da cooperativa com transmissão ao vivo para todas as agências.
No hotsite exclusivo da Promoção é possível conferir a lista com todos os ganhadores da Aplicação Premiada https://www.sicredi.com.br/promocao/ aplicacaopremiada, consultar o regulamento completo e, ainda, conferir os números eletrônicos.
O Brasil registrou em 2022 a operação de 114 novas plantas de biogás, aumento de 15% em relação ao mesmo período do ano passado. Os números são do Panorama do Biogás no Brasil em 2022, lançado pelo Centro Internacional de Energias Renováveis e Biogás (CIBiogás), instalado no Parque Tecnológico Itaipu (PTI), em Foz do Iguaçu (PR).
De acordo com o estudo, o País tem hoje 936 plantas de biogás instaladas, sendo 885 unidades em operação, produzindo aproximadamente 2,8 bilhões de metros cúbicos normais por ano (Nm³/ano).
Entre as aplicações energéticas do
biogás, o biometano se destaca com um crescimento de 82% no número de plantas. Essas unidades convertem 22% do biogás produzido no Brasil – são 359,8 milhões Nm³/ano de bio-

metano, o equivalente a rodar 3.598 milhões km/ano com veículos leves e 900 milhões km/ano com veículos pesados.
“O biogás e o biometano estão se destacando dentre outras energias. Na agropecuária, vimos que o crescimento foi significativo, sendo responsável por 63% do total das plantas que entraram em operação em 2022. Isso é muito importante, pois traduz como as fontes renováveis são essenciais para todo o tipo de setor e como podem impactar positivamente várias cadeias produtivas”, diz o diretor-presidente do CIBiogás, Rafael González.
Toledo aparece no mapa da produção de biogás e biometano como forma de viabilizar a atividade pecuária e estimular seu crescimento com a solução de um passivo ambiental.
Os produtores rurais, Maria e Emílio Angst, proprietários de um sítio de três hectares inauguraram uma unidade de geração de energia para viabilizar e até ampliar a criação de suínos e gado leiteiro, além de novos investimentos projetados para a piscicultura.
nova autorização do Instituto Água e Terra para ampliar a produção”, explica Herlon Goelzer de Almeida, coordenador estadual do Programa Paraná Energia Rural Renovável (RenovaPR).
a própria energia, resolve um passivo ambiental, provocado pela produção de dejetos animais não tratados e obtém
De acordo com ele, com esta tecnologia de biodigestores, a propriedade fica preparada para criar 19,2 mil suínos por ano, quase três vezes mais que a produção atual de 4,18 mil suínos/ano. O rebanho de vacas leiteiras deve passar de 28 para 100 animais. “Além disso, vão poder introduzir a piscicultura, com previsão de oferecer ao mercado cerca de 48 toneladas de peixes por ano”, reforça.

Em outra linha de atuação semelhante para geração de energia, integrantes do Pacto Brasileiro pelo Hidrogênio Renovável, reivindicam ao governo algumas medidas de apoio ao mercado
“Com o investimento de R$ 1,4 milhão, recursos do Plano Safra, e a instalação do biodigestor, a família, além de gerar de hidrogênio renovável e propostas de políticas públicas. Entre as medidas propostas pelo grupo, destacam-se a inserção do hidrogênio renovável na Política Energética Nacional, condições
mais favoráveis de financiamento e redução da carga tributária e créditos fiscais para a cadeia produtiva da produção do hidrogênio de fonte renovável.

Ganhar o mundo é o sonho de quase todos os estudantes e muitos já estão experimentando esse gostinho ao preparar toda documentação pessoal, como o passaporte, para embarcar no começo de 2024 para um intercâmbio todo custeado com recursos públicos do Governo do Paraná. Por meio do programa Ganhando o Mundo, 39 estudantes do Núcleo Regional de Educação (NRE) de Toledo foram convocados para a partir do primeiro semestre do ano que vem ter uma experiência incrível de intercâmbio na Austrália, Canadá, Estados Unidos, Inglaterra e Nova Zelândia. Serão meses de muito aprendizado que certamente levarão para vida toda.
O Programa Ganhando o Mundo é um programa de intercâmbio criado pelo Governo do Estado e oferecido aos estudantes, professores e pedagogos da rede pública do Paraná. Do Núcleo Regional de Assis Chateaubriand, além de estudantes, uma professora está de malas prontas para o Canadá.
O Programa Ganhando o Mundo tem por objetivo propiciar formação
acadêmica em instituições estrangeiras, além de experiências culturais e pedagógicas que possam ser compartilhadas, posteriormente, nos colégios estaduais do Paraná. Nessa etapa do programa o Governo do Estado levará ao todo 1.000 estudantes para fazer essa experiência.
1 - Gabriele Laís Oberger - CE Prof. Ildo José Fritzen
GUAÍRA

1 - Guilherme dos Santos Silva - CEC Ver. Samuel Benck
2 - Kamilly da Silva - CEC Ver. Samuel Benck
MARECHAL CÂNDIDO RONDON
1 - Yasmin Daronch - CE Monteiro Lobato
2 - Victor Hugo Kleinschmidt dos Santos Berto - CE Eron Domingues
3 - Lohane Vitória Ayres Vorpagel - CE C-M
Marechal Rondon
MARIPÁ
1 - Fernanda Kerkhoven - CE Pio XII
2 - Emanuel Gorone Ferreira - CE Pio XII
3 - Michele Jung - CE Pio XII
4 - Gabrielle Dreyer Areco - CEC Castro Alves
MERCEDES
1 - Luana Caroline Weber - CE Leonilda Papen
NOVA SANTA ROSA
1 - Emilly Bloedown Kelm - CE Mal. Gaspar Dutra
PALOTINA
1 - Thiago Soder de Souza - CEC Prof. Eugênio Garmatz
2 - Camila Eduarda Mertens Kloehn - Colégio Agrícola Estadual Adroaldo Augusto Colombo
ATRO PONTES
1 - Victore Augusto Marion de Souza - CE Quatro Pontes
TERRA ROXA
1 - Lourenzo Francisco Balonekr dos Santos - CE Antonio Carlos Gomes
2 - Kevin Ruan de Souza Schulz - CEEP Paulo
Renato Souza
3 - Éverton Gabriel Cesário Marcondes - CEEP
Paulo Renato Souza
4 - José Eduardo Souza da Silva - CEC Santa Rita D’Oeste
TOLEDO
1 - Thaynara Carolina de Paula - CE C-M Novo Horizonte
2 - Alana Louisy Becker - CE C-M Novo Horizonte
3 - Morgana Bertoldo - CE Pres. Castelo
Branco
4 - Nina Azevedo Penna Forte - CE Pres. Castelo Branco
5 - Cintia Rodrigues Pires - CE Pres. Castelo

Branco
6 - Rafaella Simionato das Chagas - CE Pres. Castelo Branco
7 - Rafaela Bosio Wurmeister - CE Jardim
Gisele
8 - Jefther Gabriel da Cruz - CE Sen. Attílio
Fontana
9 - Daniel Carvalho do Amaral - Colégio
Agrícola Estadual de Toledo
10 - Giulia Carolina Lopes - CE Dario Vellozo
11 - Letícia Lima Keitel - CE Luiz Augusto
Morais Rego
Embora a Atrofia Muscular Espinhal (AME) esteja relacionada na quinta etapa de implantação do novo número de doenças que podem ser detectadas pelo Teste do Pezinho, no âmbito do Sistema Único de Saúde (SUS), não há expectativa de quando ela será efetivada. A Lei 14.154, de 26 de maio de 2021, estabeleceu a ampliação de seis para 50 o número das doenças que podem ser detectadas pelo Teste do Pezinho. A lei federal passou a vigorar em 27 de maio de 2022 e deu aos estados prazo de quatro anos para a incorporação das 50 doenças. A neurofisiologista e neurologista Marcela Câmara Machado, membro da Academia Brasileira de Neurologia (ABN), disse que está se tentando sensibilizar os estados para que se mobilizem e acelerem a implantação das novas doenças, “mas ainda não há previsão para que a AME seja incorporada de fato ao Teste do Pezinho”.
“O objetivo desse teste é o diagnóstico precoce. Porque a gente já sabe que todas as medicações por via terapia gênica, que é hoje a terapia mais cara do mundo, têm muito mais efeito se a criança é ainda sem sintomas. Ou seja, a gente diagnostica logo que ela nasce, antes de manifestar os sintomas, para ter uma vida, senão normal, muito próxima do normal”, afirmou a especialista.
Estima-se que a incidência seja de uma pessoa com AME para cada 10 mil nascidos. No Brasil, são muitas crianças com essa doença considerada rara. Marcela informou que, na Bahia, são entre sete e oito crianças nascidas com a doença, por ano. No Brasil, o número se aproxima de 50 a 60 novas crianças a cada ano. “É um número alto para uma doença tão complexa”, salienta. Já de acordo com a Associação Brasileira de Amiotrofia Espinhal (Abrame), o país tem hoje cerca de 300 novos casos de AME por ano.
A AME não tem cura. “Os tratamentos são para otimizar e dão melhor resultado, se os diagnósticos são feitos precoce-
mente. Mas ainda não tem cura, apesar dessa terapia genética que se propõe a melhorar a função do indivíduo, recompor a função que é perdida, do ponto de vista genético. A gente não sabe, inclusive, se essa terapia genética terá de ser repetida na pessoa na fase adulta, por exemplo. Não há ainda estudos para isso”, advertiu a neurologista. O que se sabe, atualmente, é que quanto mais precoce a criança é tratada, ela tem um desfecho melhor, destacou a médica.

De acordo com o Ministério da Saúde, a atrofia muscular espinhal (AME) é uma doença rara, degenerativa, passada de pais para filhos e que interfere na capacidade do corpo de produzir uma proteína essencial para a sobrevivência dos neurônios motores, responsáveis pelos gestos voluntários vitais simples do corpo, como respirar, engolir e se mover. “Os indivíduos nascem com uma alteração genética que perde os neurônios, nervos responsáveis pelos movimentos, que estão na região da medula”. A alteração genética faz com
que não haja produção de uma substância que deixa esse neurônio saudável.
No âmbito do SUS, há um medicamento denominado Spinraza. Recentemente, foi incorporado outro remédio, chamado Risdiplam, mas os médicos estão aguardando sua publicação e atualização do protocolo. “Como é uma medicação oral, que depende de preparo de farmácia, os estados estão se organizado para ver a questão de logística. Está para ser publicado”, comenta.
A terceira medicação é a terapia gênica (Zolgensma). A Comissão Nacional de Incorporação de Tecnologias no Sistema Único de Saúde (Conitec) já deu parecer favorável, mas o medicamento não foi ainda incorporado pelo guia PCDT (Protocolos Clínicos e Diretrizes Terapêuticas). Essa terapia foi liberada para crianças até seis meses de idade. “Mas se a gente não consegue diagnosticar precocemente, não vai conseguir tratá-las com essa terapia”, ressaltou a médica.
Outubro é um mês de grande significado para as mulheres. É o mês que convoca o público feminino a um olhar mais atento para a saúde, especialmente na prevenção ao câncer de mama. O grande desafio para a saúde pública, rede suplementar e particular na Campanha Outubro Rosa é motivar as mulheres à retomada da prática de exames periódicos.


Contudo, além de ser muito difícil enfrentar a doença, não são raras as situações em que a mulher tem que encarar sozinha o câncer de mama. Cerca de 85% das mulheres que têm a doença são abandonadas pelos seus parceiros, muitas delas com filhos, conforme revelado pelo Instituto Humanista de Desenvolvimento Social, em debate sobre o tema na Assembleia Legislativa do Paraná (2022). É um dado chocante que, lamentavelmente, expressa a falta de amor, indiferença e irresponsabilidade de um grupo masculino.
Grande parte da prevenção acontece em casa quando em seu momento íntimo. Em caso de identificação de algo anormal na mama, procure rapidamente o atendimento médico, especialmente se perceber um caroço (nódulo), geralmente endurecido, fixo e indolor. Essa é a recomendação do Instituto Nacional do Câncer (Inca), que reforça: independentemente da idade isso deve ser feito. A mulher também precisa estar atenta a pequenos caroços no pescoço ou axilas.
Em 2021, a Sociedade Brasileira de Mastologia registrava queda de 70% na busca de mulheres por serviços médicos voltados à prevenção do câncer de mama. No ano passado ainda eram 60%. Estima-se que esse ano o índice melhore e mais mulheres estejam atentas à prevenção. A mamografia de rastreamento é recomendada para mulheres sempre com acompanhamento médico. Atualmente, se fala em uso da inteligência
artificial para auxiliar na detecção dos casos, mas os pesquisadores alertam para a necessidade de novos estudos.
Também em fase de testes está outro sistema que se encontra na formação da base de dados para posteriormente comparar resultados de mamografia e auxiliar no diagnóstico e tratamento. Enquanto isso, resta para a mulher e sua família atuarem de maneira conjunta na prevenção. Individualmente, a mulher deve procurar ter uma rotina de alimentação saudável e prática regular de exercícios físicos, porém que sejam dedicados em horário de atenção para elas. Uma caminhada no começo do dia ou no entardecer, de maneira relaxante e descontraída, contribui nesse processo saudável e de qualidade de vida. Mas isso precisa estar associado à boa alimentação, evitando consumo de bebida alcoólica e com a realização de exames de rotina. A rede pública de saúde do Paraná oferece 173 mamógrafos com exames realizados pelo Sistema Único de Saúde (SUS).
Ainda sobre as atividades realizadas durante a Semana Nacional da Família de 2023, pais e filhos se reuniram na Igreja São Luiz Gonzaga, em Pato Bragado, para um momento de partilha e de reflexão sobre esse dom precioso que é família. O evento contou com a participação do Grupo Kaskata. Ao final, o pároco, Pe. Antonio Carlos Pereira da Silva, conduziu o rito de bênção aos participantes – Fotos: Pascom





Familiares e amigos da Paróquia São Cristóvão, de Toledo, cumprimentam Pedro Donadel (17/10) e Lúcia Bertoldi Donadel (21/10) pelos seus respectivos aniversários, pedindo a bênção de Deus sobre suas vidas e desejando-lhes muita saúde e felicidades
ENVIE SUA FOTO



Catequistas da Capela São Luiz Gonzaga – Paróquia Menino Deus - recebem homenagem dos pais e catequizandos, da equipe de Liturgia e da comunidade com lembrancinhas que demonstram carinho e admiração por essa missão que exercem em prol das famílias e da própria comunidade. Dentre as frases inspiradoras, a catequista Ana recebeu: “Ser catequista requer amor cada vez mais forte a Cristo, amor ao seu povo santo. Obrigado pelo compromisso de fé e amor”






Encontro de formação da Pastoral da Pessoa Idosa para coordenadores do Decanato Toledo, com participação de oito paróquias. O conteúdo apresentado foi o material do curso de facilitador (5/09)



Essa turminha é acompanhada pela catequista Nica e a ajudante Paola, da Paróquia São Roque (Nova Aurora). Os catequizandos participaram de uma atividade alusiva ao Mês da Bíblia, na qual percorreram os arredores da Igreja Matriz com a Bíblia na mão e levando o Evangelho a quem encontrassem. Nas abordagens, alguns “nãos” foram recebidos, mas nada que tirasse o brilho no olhar das crianças que ofereceram a Palavra de Deus.
















Catequistas da Paróquia Nossa Senhora de Fátima, de Maripá, com Frei Gabriel de Moura Lima – Foto: Sandra Moreira
A Igreja Matriz Nossa Senhora de Fátima, de Maripá, acolheu a celebração em homenagem a São Tarcísio, padroeiro dos coroinhas e acólitos, ocasião em que homenageou 12 crianças do Projeto Sementinhas, 11 coroinhas e três que estão em formação para acólitos, as quais são acompanhadas por seis catequistas e auxiliares – Foto: Sandra Moreira

Homenagem aos Catequistas da Paróquia Cristo Rei, de Entre Rios do Oeste

A Paróquia Nossa Senhora de Fátima, de Maripá, celebrou a Assunção de Nossa Senhora e o Dia da Família com a participação da Pastoral Familiar Na ocasião, foi revelada a experiência de fé da família do jovem Vitor Gabriel Pereira dos Santos – Foto: Sandra Moreira
Grupo JUC de Formosa do Oeste marcou presença no Acampamento Kairós, organizado pela Pastoral da Juventude do Decanato Assis


Participantes do Grupo de Jovens JUEM, da Paróquia Nossa Senhora do Carmo, no Acampamento Kairós realizado em Assis Chateaubriand pela Pastoral da Juventude

Galera do Grupo de Jovens JAC, da Capela São Miguel – Paróquia Nossa Senhora do Carmo reunida para registrar a presença no Acampamento Kairós, organizado pela Pastoral da Juventude do Decanato Assis



Mães da Paróquia Nossa Senhora Aparecida (Terra Roxa) participaram do Encontro Estadual do Movimento Mães que Oram pelos Filhos em Braganey (2 e 3 /09)





















Gustavo Alberto Pavan, natural de Palotina (PR), 30 anos, professou seus Votos Perpétuos na Congregação dos Padres Marianos da Imaculada Conceição da Santíssima Virgem Maria (8/09), na Paróquia São Jorge, em Curitiba – Fotos: Raphael Pereira

Acólitos e coroinha que participaram da celebração com rito do Sacramento da Crisma na Paróquia Nossa Senhora Aparecida, de Guaíra. Na foto com o bispo diocesano, D. João Carlos Seneme, e com o pároco, Pe. Nelton Hemekmeier




O caminho ao Matrimônio passas pelo casal permitir que a Sagrada Família – Jesus, Maria e José – façam parte do novo lar que vai se constituir. Para isso, é necessário colocar em primeiro lugar a preparação para receber o Sacramento do Matrimônio. Estes casais participaram da catequese matrimonial na Paróquia Santo Inácio de Loyola (Jesuítas), com atuação da Pastoral Familiar. Que sejam abençoados na vocação para a família – Fotos: Patrícia Pelissari









2º Encontro Diocesano do Movimento Mães que Oram pelos Filhos, realizado na Paróquia Nossa Senhora Aparecida, de Terra Roxa (16/07). O evento fortaleceu laços das mulheres que se colocam diante de Nossa Senhora para rezar pelos filhos, com momentos de formação oferecidos pelo Movimento com o tema “Vinde minhas filhas, não tenhais medo”.



Crianças fazem representação de Nossa Senhora da Salette, Maximim Giraud e Melanie Calvat no Encontro Diocesano
Kelly Bitencourt (Paróquia São Roque, Nova Aurora), Neyva Martini (Paróquia Nossa Senhora Aparecida, Terra Roxa), Marilene Burim (Paróquia São Vicente Palotti, Palotina), Elaine Volpato (Paróquia Santa Rosa de Lima, Nova Santa Rosa) e Edinéia Vasconcelos (Paróquia Nossa Senhora Aparecida, Terra Roxa)
Lisnéia Duarte (Serviço Estadual AMO-Hospital), Neyva Martini (coordenadora diocesana), Kátia Golombe (Serviço Estadual de Formação) e Edineia da Silva (coordenadora de Grupo)


















O 18º Congresso Diocesano do Apostolado da Oração e Movimento Eucarístico Jovem (MEJ), realizado em Toledo, no Seminário Santa Mônica, ocorreu em final de agosto com a marcante presença dos membros desta grande rede de oração do Papa. A coordenadora diocesana, Lourdes de Assis, apresentou sua gratidão a todos os envolvidos que possibilitaram a realização do evento e ofereceu alguns brindes em agradecimento.













O Terço vocacional rezado na Paróquia Santa Rosa de Lima, de Nova Santa Rosa, por ocasião da Jornada de Oração pelas Vocações contou com pleno envolvimento da garotada da Catequese e famílias. Desde a preparação do ambiente com decoração até a animação e cantos. Com as tarefas distribuídas, a oração foi feita enquanto as crianças e adolescentes formaram um Terço no chão a partir de representações dos passos que são dados diariamente na comunidade de fé. Ao final, uma adolescente representou Nossa Senhora, primeira discípula.



 Membros do Apostolado da Oração da Paróquia Nossa Senhora das Graças (Novo Sarandi) que participaram do Congresso Diocesano realizado em Toledo
Membros do Apostolado da Oração da Paróquia Nossa Senhora das Graças (Novo Sarandi) que participaram do Congresso Diocesano realizado em Toledo
A Embrapa Suínos e Aves (SC) vem avançando no desenvolvimento de um protótipo de biofármaco à base de bacteriófagos para controlar salmonelas avícolas, que causam contaminação da carne de frango e salmonelose em humanos. Bacteriófagos são vírus amplamente distribuídos na natureza e que atuam especificamente sobre bactérias. Essa ação bactericida representa uma alternativa ao uso de antibióticos. Pesquisadores isolaram e estudaram três desses vírus, que compõem a coleção de microrganismos da Unidade, e reúnem as características desejadas para controle de determinados sorotipos de salmonela.

A pesquisa atende a uma das prioridades da produção animal atualmente – a manutenção de rebanhos e plantéis livres de patógenos que causam doenças transmitidas por alimentos, e assim garantir a inocuidade dos produtos. A resistência a antimicrobianos é um dos temas mais relevantes nesse contexto, e tem direcionado políticas públicas pela interface com o conceito de saúde única, pela inter-relação com saúde humana, animal e meio ambiente.
A disseminação de microrganismos multirresistentes aos antimicrobianos
disponíveis e a falta de desenvolvimento de novas classes de antimicrobianos têm motivado o alerta de especialistas para a dificuldade futura de enfrentamento de bactérias, mesmo em infecções simples.
De acordo com a pesquisadora Clarissa Vaz, líder do projeto que resultou no desenvolvimento do protótipo de biofármaco à base de vírus bactericidas, a disponibilidade de um ativo biológico, que evita ou reduz o uso de antimicrobianos e seja aplicável ao controle de salmonela na avicultura, é desejável frente à importância social e econômica da produção avícola para o País e à necessidade de uso prudente dos
antimicrobianos para preservar a eficácia dos que estão disponíveis. “Esse insumo não pretende substituir o uso terapêutico de antibióticos, mas é uma opção para reforçar o controle de salmoneloses, reduzindo o uso desnecessário de antimicrobianos”, explica.
Ainda segundo Vaz, insumos biológicos à base de bacteriófagos não representam necessariamente uma inovação na indústria de saúde e alimentação animal, uma vez que sua ação bactericida é conhecida há muito tempo. “O diferencial é que, se desenvolvidos produtos escalonáveis, de custo acessível, e contendo bacteriófagos adequados, a fagoterapia (uso de bacteriófagos contra infecções bacterianas) é uma possibilidade de diversificar as estratégias de controle de salmonelas aviárias”, pontua.
Outra vantagem apresentada pela pesquisadora é a de que bacteriófagos nativos são interessantes para o desenvolvimento de produtos voltados ao mercado nacional por não introduzirem cepas exóticas na biodiversidade brasileira e apresentarem maior probabilidade de ação frente às estirpes de campo locais.
Os estudos levaram ao desenvolvimento do protótipo de um biofármaco que é fornecido aos frangos pela água de beber, capaz de reduzir o nível de salmonela no intestino de frangos de corte. “O desafio atual é avançar nas etapas de desenvolvimento até a fase de produção continuada, em condições
de inserção no mercado. Esse é um processo que segue a lógica de inovação aberta e repartição de benefícios, por meio da qual a Embrapa e empresas interessadas desenvolvem a pesquisa juntas com o objetivo de desenvolver os seus produtos e aumentar o valor agregado”, observa a pesquisadora.
O Governo Federal atualizou as medidas que podem ser adotadas para enfrentamento de emergências fitossanitárias ou zoossanitárias de que trata a Lei nº 12.873/2013, que autoriza a declaração de estado de emergência relacionado às atividades da defesa agropecuária.
A Medida Provisória nº 1.186 foi publicada no Diário Oficial. A partir dela, autoridades públicas do Sistema Unificado de Atenção à Sanidade Agropecuária (Suasa) poderão adotar as seguintes medidas: estudo ou investigação epidemiológica e restrição excepcional e temporária de trânsito de produtos agropecuários por qualquer modal logístico no território nacional e internacional.
Também poderão determinar medidas de contenção, desinfecção, desinfestação, tratamento e destruição aplicáveis a produtos, equipamentos e instalações agropecuários, e a veículos em trânsito nacional e internacional no país; e realização ou determinação da realização compulsória de ações de mitigação e controle fitossanitário e zoossanitário.
A União poderá doar materiais, equipamentos e insumos considerados indispensáveis para o enfrentamento de emergência fitossanitária ou zoossanitária a órgãos e entidades federais, estaduais, distritais e municipais mobilizados, independentemente do cumprimento, por parte do beneficiário, dos requisitos legais de adimplência exigíveis para a celebração de ajuste com a administração pública federal.
A Medida Provisória também autoriza o Ministério da Agricultura e Pecuária (Mapa) a custear despesas de deslocamento de servidores e empregados públicos de outras instâncias do Suasa
que atuarem em operações de defesa agropecuária convocadas pelo Ministério.
Além disso, o texto altera a Lei nº 8.745/1993 para incluir na possibilidade de contratação de excepcional interesse público, que prescinde de processo seletivo, as situações de iminente risco à saúde animal, vegetal ou humana, fitossanitária ou zoossanitária.
O Governo Federal já realizou, neste ano, outras iniciativas para combater a influenza aviária — doença grave e de alta letalidade para aves domésticas e silvestres, com potencial para causar prejuízos econômicos ao país.

Em maio, o Mapa declarou estado de emergência zoossanitária em todo o território nacional, por meio da Portaria nº 587/2023, em função da detecção da infecção pelo vírus da influenza aviária de alta patogenicidade (IAAP) - H5N1 -
em aves silvestres no Brasil. Em junho, a Medida Provisória nº 1.177/2023 abriu crédito extraordinário para enfrentamento do estado de emergência zoossanitária. O Mapa tem trabalhado em articulação com diferentes Ministérios e órgãos federais para prevenção e atuação frente aos possíveis impactos da disseminação da doença no Brasil. Cabe lembrar que todas essas medidas apresentam como objetivo a pronta resposta às autoridades internacionais de sanidade animal e adoção de práticas que não interrompam o fluxo de exportações do país como um todo, mas, dentro do possível, em situações pontuais. Com isso, a previsão é que –em caso de ocorrência da IAAP – seja possível acelerar os processos de retomada da comercialização, baseados na estratégia adotada e na indicação clara e precisa de como se dará todo o trabalho pela autoridade sanitária brasileira e dos estados.

Nossa Senhora da Conceição, luz divina, Aparecida, estrela que nos guia, Com teu manto, protege-nos, Maria, Na fé que em teu nome se ilumina.

Ó Mãe Bendita, rainha da esperança, Teu amor e graça nos alcançam, Na vida e na morte, és nossa guia.
Com devoção, aqui te aclamamos, Teu nome, Maria, sempre exaltamos, Nossa Senhora, nossa Mãe querida, Mãe Aparecida.
Marisa Aparecida Carvalho de Souza
Paróquia Sagrada Família Toledo/PR
Senhor, eu ponho em vós minha esperança (...);
Sede uma rocha protetora para mim, um abrigo bem seguro que me salve!
Sim, sois vós a minha rocha e fortaleza;
por vossa honra orientai-me e conduzi-me!
A vós, porém, ó meu Senhor, eu me confio,
e afirmo que só vós sois o meu Deus!
Eu entrego em vossas mãos o meu destino;
libertai-me do inimigo e do opressor!
Como é grande, ó Senhor, vossa bondade,

A Virgem Maria, mulher de fé inabalável, mostra para nós cristãos como deve ser a confiança em Deus. Ela é um exemplo inspirador de total entrega da sua vida. Virtuosa, ela nos ajuda a seguir rumo ao Reino celeste. Mesmo diante das incertezas da vida, ela nos mostra que há um plano divino que guia nossos passos.
Sua confiança em Deus a fortaleceu nos momentos difíceis, mas com serenidade deixou-se guiar pelo Senhor. Maria ensina que é preciso soltar o controle sobre as circunstâncias e acreditar que tudo acontece pela vontade de Deus.


Juliana Alves de Morais
Paróquia São Francisco de Assis - Toledo/PR
que reservastes para aqueles que vos temem!
Para aqueles que em vós se refugiam, mostrando, assim, o vosso amor perante os homens.
Salmo 30(31)


Aponte a câmera do seu celular!


